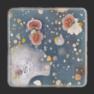

November Novembre 2022 The Top 10: These are Canada’s Best New Restaurants Le palmarès : voici les Meilleurs nouveaux restos canadiens

Scale new heights in the Rockies and Laurentians. Soak up the sun in Mexico and the Caribbean. This winter, go beyond limits with Fairmont Hotels & Resorts and ALL – Accor Live Limitless. Embrace the season and enjoy 25% OFFup to VISIT FAIRMONT.COM








On the covers
couverture
A taste of the top three: from organic halibut and zucchini blossom in vermouth sauce to scallops and chanterelles in a smooth green-pea emulsion, and chili oil-slicked belt noodles. Un avant-goût du Top 3 : du flétan bio et fleur de courgette en sauce au vermouth, des pétoncles et chanterelles avec onctueuse émulsion de petits pois, et des nouilles ceintures étincelantes d’huile de chili.
Photos by de Virginie Gosselin
Novembre
Take Off Envol
CANADIAN CHEF JESSICA ROSVAL TELLS US WHERE TO EAT IN MODENA



LA CHEFFE CANADIENNE
JESSICA ROSVAL NOUS DIT

OÙ MANGER À MODÈNE
CREATORS DISH ON COOKING FOR THE INTERNET AND REDEFINING CANADIAN CUISINE TROIS CONCEPTEURS CULINAIRES


LA CUISINE DU WEB ET LA REDÉFINITION DE LA GASTRONOMIE CANADIENNE

WORLD CLASS BARTENDER JAMES GRANT’S
FOR COCKTAIL-PAIRING SUCCESS

ACCORDS COCKTAIL-BOUFFE RÉUSSIS
WORLD CLASS BARMAN JAMES GRANT
5IN THIS ISSUEDANS NOS PAGES November —
2022
10 CONTRIBUTORS COLLABORATEURS 12 LETTER FROM OUR EDITORIAL DIRECTOR LE BILLET DE LA DIRECTRICE DE LA RÉDACTION 15 LETTER FROM AIR CANADA LE BILLET D’AIR CANADA 19 IN TOWN EN VILLE 22 THE CONVERSATION LA CONVERSATION 30 AIR CANADA ENROUTE × DIAGEO
En
PHOTOS ASHLEY VAN DER LAAN (30). ILLUSTRATIONS: IRENE RINALDI (19); PAUL RYDING (22).
19 30
RECIPES
DES
DU
THREE
SUR
22
CANADA’S BEST NEW RESTAURANTS 2022


MEILLEURS NOUVEAUX RESTOS CANADIENS 2022
THE COUNTRY
WAY
OUR ROVING FOOD CRITIC
SEARCH OF THE TOP 10 NEW SPOTS NOTRE CRITIQUE GASTRONOMIQUE ITINÉRANTE SE RÉGALE PARTOUT AU PAYS, À LA RECHERCHE DES 10 MEILLEURS NOUVEAUX ÉTABLISSEMENTS
91 INSIDE AIR CANADA PROFIL D’AIR CANADA 92 WHERE WE FLY NOS DESTINATIONS 98 SHARE YOUR VIEWS DE VOTRE POINT DE VUE

ILLUSTRATION: SALINI PERERA (68).
AIR CANADA ENROUTE × AMERICAN EXPRESS
THE MOST CRAVE-WORTHY DISHES WORTH FLYING FOR ACROSS CANADA DES PLATS CANADIENS ALLÉCHANTS QUI VALENT LE DÉPLACEMENT

SPIRITED AWAY L’ÂME DU MALT
DRINKING SUSTAINABLE WHISKY IN THE SCOTTISH HIGHLANDS BOIRE DU WHISKY ÉCOLOGIQUE DANS LES HIGHLANDS ÉCOSSAIS

NOW BOARDING FOR BANGKOK EMBARQUEMENT POUR BANGKOK
SURVIVAL OF THE SWEETEST LA SURVIE DU PLUS SUCRÉ
VISITING THE KING OF QUEENS IN QUEBEC’S HAUTES-LAURENTIDES VISITER LE ROI DES REINES DANS LES HAUTES-LAURENTIDES DU QUÉBEC
98
A READER CAPTURES COFFEE CHERRIES IN COSTA RICA UNE LECTRICE PHOTOGRAPHIE DES CERISES DE CAFÉ AU COSTA RICA

More stories —— Pour plus d’histoires enroute.aircanada.com @enroutemag
PHOTOS: VIRGINIE GOSSELIN (32); ÉRIVER HIJANO (70); DOMINIQUE LAFOND (78); LAIRD KAY (91); STEPHANIE MADEIRA (98).
6 DANS NOS PAGESIN THIS ISSUE
Features Reportages Altitude
68 70
LES
32
EATS HER
ACROSS
IN
91
78

CONTENT DIRECTOR DIRECTRICE DES CONTENUS
Louise Upperton
EDITORIAL RÉDACTION
EDITORIAL DIRECTOR DIRECTRICE DE LA RÉDACTION
Katie Sehl
CONTENT STRATEGIST STRATÈGE DE CONTENU
Renée Morrison
EDITORIAL ASSISTANTS ADJOINTES À LA RÉDACTION
Monica Ferguson, Alexis Ramlall
SOCIAL MEDIA MANAGER GESTIONNAIRE DE MÉDIAS SOCIAUX Billie Gagné-Lebel
ART CONCEPTION VISUELLE
ART DIRECTOR DIRECTRICE ARTISTIQUE
Stefanie Sosiak
PHOTO EDITOR RESPONSABLE PHOTO Lori Morgan
SENIOR GRAPHIC DESIGNERS, DIGITAL GRAPHISTES PRINCIPAUX, NUMÉRIQUE
Léandre Martin-Meilleur, Nicolas Venturelli
CONTRIBUTORS COLLABORATEURS
Renée Drexler, Ronke Edoho, Virginie Gosselin, Ériver Hijano, Laird Kay, Evaan Kheraj, Jon Kung, Dominique Lafond, Nancy Matsumoto, Brian Morgan, Salini Perera, Irene Rinaldi, Paul Ryding, Shayma Owaise Saadat, Caitlin Stall-Paquet, Ashley van der Laan
CONTRIBUTING EDITORS RÉDACTEURS COLLABORATEURS
Benoît Brière, Andrew Elkin
PRODUCTION
SENIOR PRODUCTION MANAGER RESPONSABLE PRINCIPAL DE LA PRODUCTION

Felipe Batista Nunes
PRODUCT MANAGER, DIGITAL CHEF DE PRODUITS, NUMÉRIQUE Ian Gamache
PRODUCT AND CONTENT MANAGER GESTIONNAIRE DE PRODUIT ET DE CONTENU Nancy Kovacs
PROOFREADERS CORRECTRICES
Diane Carlson, Annie Trudel

TRANSLATORS TRADUCTEURS
Frédéric Arcand, Marie-Josée Arcand, Vincent Fortier, Waguih Khoury, Marie Mello, Isabelle Vialle-Soubranne
FACT CHECKERS VÉRIFICATRICES D’INFORMATION
Tara Dupuis, Monica Ferguson, Corinna Reeves
COPY AND LINE EDITORS RÉDACTEURS-RÉVISEURS
Christopher Korchin, Liette Lemay, Robert Ronald, Isabelle Wolfmann
SPAFAX CANADA
ADVERTISING AND MEDIA SALES VENTES MÉDIAS ET PUBLICITAIRES
SALES TEAM CANADA ÉQUIPE DES VENTES AU CANADA
Rysia Adam, Susan Perlanski, Edweina Saurin, Jennifer Woolcombe
DIRECTOR OF SALES NORTH AMERICA DIRECTRICE DES VENTES POUR L’AMÉRIQUE DU NORD Mary Rae Esposito
ADVERTISING PRODUCTION PRODUCTION PUBLICITAIRE Stephen Geraghty, Mary Shaw
CHIEF CLIENT OFFICER AND PUBLISHER DIRECTEUR DES RELATIONS AVEC LES CLIENTS ET ÉDITEUR Raymond Girard
MANAGING DIRECTOR DIRECTEUR GÉNÉRAL Alex Glavonich
HEAD OF MARKETING AND BRAND PARTNERSHIPS CHEFFE DU MARKETING ET DES ALLIANCES DE MARQUES Karen Kelar
GROUP ACCOUNTS AND STRATEGY LEAD RESPONSABLE DES COMPTES DE GROUPES ET DE LA STRATÉGIE Elana Crotin
ACCOUNT COORDINATOR COORDINATEUR DE COMPTE Farhaan Somani
DIRECTOR OF OPERATIONS DIRECTRICE DES OPÉRATIONS Sharon Adonis
OFFICE BUREAU 155 Queens Quay East Toronto, Ontario M5A 0W4 416-350-2425 Fax 416-350-2440
CONTACT AIR CANADA ENROUTE POUR ÉCRIRE À AIR CANADA ENROUTE info@aircanadaenroute.com
FOR MEDIA SALES ENQUIRIES, CONTACT —— POUR LES DEMANDES RELATIVES AUX VENTES MÉDIAS, CONTACTEZ sales@aircanadaenroute.com
With our environmentally friendly Sappi paper, this issue of Air Canada enRoute produces three times fewer CO 2 emissions than the industry average. This means diverting the equivalent of 6,577 kilograms of waste from landfill to recycling. Greenhouse gas emissions calculations are courtesy of the United States Environmental Protection Agency. epa.gov/energy.
© 2022 Air Canada enRoute is published by Spafax Canada Inc. All rights reserved.
Points of view expressed do not necessarily represent those of Air Canada. Indexed in the Canadian Periodical Index ISSN 0703-0312
Canada Post Publications Mail Agreement Number 40027112 spafax.com
Imprimé sur écopapier de Sappi, ce numéro d’Air Canada enRoute produit trois fois moins d’émissions de CO 2 que la moyenne dans l’industrie. Ceci équivaut à détourner des décharges 6577 kg de déchets vers le recyclage. Calculs des émissions de GES gracieuseté de l’Environmental Protection Agency des États-Unis. epa.gov/energy.
© 2022 Air Canada enRoute est publié par Spafax Canada Inc. Tous droits réservés. Les points de vue formulés sont ceux des auteurs et ne représentent pas nécessairement ceux d’Air Canada. Répertorié dans l’Index des périodiques canadiens ISSN 0703-0312

Poste-publications numéro de convention 40027112 spafax.com
AIR CANADA VICE-PRESIDENT, BRAND VICE-PRÉSIDENT – MARQUES Andy Shibata
MANAGER, PRODUCT DESIGN CHEF DE SERVICE – CONCEPTION DES PRODUITS Hali Hamilton
8 FAIT PARMADE BY
ONLINE EXCLUSIVE EXCLUSIVITÉ WEB
Read more exclusive stories at Pour plus d’articles exclusifs, visitez ENROUTE.AIRCANADA.COM
Martha
Stewart’s Guide to Las Vegas Le Las Vegas de Martha Stewart
PHOTO: THE BEDFORD BY MARTHA STEWART

Style Shown: CK22540
Special Thanks to — Remerciements à
Virginie Gosselin Photographer Photographe
 Ériver Hijano Photographer Photographe
Ériver Hijano Photographer Photographe
SPIRITED AWAY
L’ÂME DU MALT p. 70
Hidden-gem destination Destination méconnue
I am really in love with Andalusia in southern Spain at the moment. There are so many wonderful little villages and empty beaches, and I find the desert vibe unique.
En ce moment, j’aime beaucoup l’Andalousie, dans le sud de l’Espagne. Les merveilleux petits villages et plages vides sont nombreux, et l’ambiance de désert est unique.
@eeeriver
CANADA’S BEST NEW RESTAURANTS
LES MEILLEURS NOUVEAUX
RESTOS CANADIENS p. 32
Where next Prochain voyage
I would like to go on a multiday backpacking trip in Kuururjuaq National Park near Nunavik. It seems so magnificent and it’s just a three-hour flight from Montreal. J’aimerais faire une longue randonnée de plusieurs jours dans le parc national Kuururjuaq au Nunavik. Tout semble magnifique, et il n’est qu’à trois heures de vol de Montréal.
@virginiegosselin
Nancy Matsumoto Writer Rédactrice

CANADA’S BEST NEW RESTAURANTS
LES MEILLEURS NOUVEAUX

RESTOS CANADIENS p. 32
Favourite souvenir Souvenir préféré
A small navy-and-gold bag made of woven sailcloth from Fukuoka, Japan. Unfortunately, I set it aflame when I unwittingly placed it near a decorative candle. Un petit sac bleu marine et or en toile à voile tissée provenant de Fukuoka, au Japon. Malheureusement, il s’est enflammé quand je l’ai involontairement placé près d’une bougie décorative.
@nancymatsumoto
Writer Rédactrice

SURVIVAL OF THE SWEETEST
LA SURVIE DU PLUS SUCRÉ p. 78
First travel memory Premier souvenir de voyage
Camping near Lake Champlain in Vermont with my family: sleeping in a lean-to structure, endless cycles of swimming and drying off, and making summer friendships that felt like they’d last forever.
Camping près du lac Champlain, au Vermont, avec ma famille : nuits dans un abri en appentis, cycles infinis de baignade et de séchage, et amitiés d’été qui semblaient pouvoir durer éternellement.
@caitlinstallp
10 COLLABORATEURSCONTRIBUTORS
PHOTOS: ANTONIA HANNEY (ÉRIVER HIJANO); VIRGINIE GOSSELIN (VIRGINIE GOSSELIN); JENNIFER ROWSOM (NANCY MATSUMOTO); HAMZA ABOUELOUAFAA (CAITLIN STALL-PAQUET).
Caitlin Stall-Paquet


In Good Company En bonne compagnie
Katie Sehl Editorial Director Directrice de la rédaction
We all have that friend. The one who can reliably tell you where to find the best food in any far-flung destination on the planet. To some of our kith and kin, we’re that friend. And if you’re like me, the call for recommendations is akin to a welcome summons for friendship jury duty. The case: Where to eat in Delft, Holland. The evidence: You wouldn’t think a chef could get away with putting tenderloin roast beef, gorgonzola, chimichurri and tangerine slices in a sandwich, but I ordered one twice in two days. The verdict: You’re going to love it.
For the fourth time in more than 20 years of Canada’s Best New Restaurants, we’ve called upon our trusted confidante, Nancy Matsumoto, to be your friend by proxy. Before she set out on her mission to find the latest and greatest places to eat across the country, we turned to our network of food writers, chefs, sommeliers and restaurateurs for insider advice on the spots she should visit. So, as you eat your way through our Top 10 list this year, consider each choice a tip from a well-informed friend of a friend.
If there are six degrees of separation between Kevin Bacon and other Hollywood actors, I wonder how many degrees closer we get to each other with each dining experience. Anthony Bourdain ate at Sora Lella in Rome, which led me to eat there on my visit, and then recommend it to friends ahead of their Roman holidays. It’s beautiful to think of our favourite meals as the result of these connections –a culmination of good meals past. And we have the tireless work of chefs and their teams, growers and purveyors to thank for bringing us together.
Over the past year I’ve done a lot of reflecting on the ways we connect over food. For many chefs and producers in this issue, food is a way to better appreciate and conserve local foodways and the bounty of the land. For creators like Ronke Edoho, Jon Kung and Shayma Saadat, cooking is a way to share and reimagine cultural traditions. For chef Scott Jonathan Iserhoff, owner of the Edmontonbased Indigenous takeout and catering restaurant Pei Pei Chei Ow, a meal is an offering that says get to know me better, and get to know you better. What could be better than that?
On a tous ce genre d’ami sur qui se fier pour savoir où manger dans n’importe quelle ville de la planète. Pour certains de nos proches, ce genre d’ami, c’est parfois nous. Si vous êtes comme moi, ces demandes de recommandations sont autant de citations bienvenues à faire un devoir d’amical juré. Affaire : où se sustenter à Delft, aux Pays-Bas. Preuve : on ne penserait pas qu’un chef puisse s’en tirer avec un sandwich mariant rosbif de filet, gorgonzola, chimichurri et tranches de tangerine, mais j’en ai commandé deux jours de suite. Verdict : vous allez adorer.
Pour la quatrième fois en plus de 20 ans des Meilleurs nouveaux restos canadiens, nous avons fait appel à notre fidèle confidente, Nancy Matsumoto, pour qu’elle soit ce genre d’amie par procuration. Avant qu’elle parte en quête des meilleures nouvelles tables du pays, nous avons consulté notre réseau de chroniqueurs culinaires, de chefs, de sommeliers et de restaurateurs pour qu’ils nous tuyautent sur les adresses qu’elle devrait visiter. Veuillez donc voir chaque établissement de notre palmarès comme le conseil avisé d’une amie d’un ami.
S’il y a six degrés de séparation reliant Kevin Bacon à tout acteur de Hollywood, je me demande de combien de degrés nous nous rapprochons les uns des autres à chaque repas au resto. À Rome, Anthony Bourdain a dîné à la trattoria Sora Lella, ce qui m’a amenée à y manger lors d’un séjour, puis à recommander l’endroit à des amis avant leurs vacances là-bas. C’est beau d’envisa ger nos repas préférés comme le résultat de tels liens, comme le fruit de superbes repas du passé. Et c’est le travail inlassable de chefs et de leurs équipes, de culti vateurs et de fournisseurs qui nous réunit.
J’ai beaucoup réfléchi depuis un an à la façon dont nous tissons des liens grâce à la cuisine. Pour bien des chefs et des producteurs présents dans ce numéro, manger permet de mieux apprécier et de préserver les usages culinaires locaux et les richesses du terroir. Pour des créateurs comme Ronke Edoho, Jon Kung et Shayma Saadat, cuisiner sert à faire connaître et à réinventer les traditions culturelles. Pour le chef Scott Jonathan Iserhoff, proprio à Edmonton du Pei Pei Chei Ow, resto de mets autochtones pour emporter avec service de traiteur, un repas est une offrande qui in vite à mieux connaître qui le prépare et qui le savoure. Qui dit mieux ?
MY FAVOURITE STORIES FROM THE ARCHIVES MES HISTOIRES PRÉFÉRÉES DES NOS ARCHIVES
Mediterranean Coast Une virée à saveur d’anchois sur la côte méditerranéennes

Why Ratatouille is Phil Rosenthal’s Favourite Food Film Pourquoi Ratatouille est le film gastronomique favori de Phil Rosenthal
Score the Best Food in Canada’s NHL Arenas C’est le but : quoi manger dans les amphithéâtres canadiens de la LNH
Hallelujah: A Pilgrimage to Leonard Cohen’s Former Home on Hydra Hallelujah : un pèlerinage à l’ancienne maison de Leonard Cohen à Hydra
Looking at the Planet from Above Changes Everything Voir la planète de haut change les perspectives
Read them online at Lisez-les en ligne à enroute.aircanada.com
LE BILLET DE LA DIRECTRICE DE LA RÉDACTIONLETTER FROM OUR EDITORIAL DIRECTOR12
PHOTO: XAVIER TERA
THE WAY YOU COOK

Vancouver · Edmonton · Calgary · Winnipeg · Toronto · Montréal · Québec · Halifax LeCreuset.ca TRANSFORM

Scan or visit aircanada.com/join JOIN NOW Scannez le code ou visitez aircanada.com/adherer INSCRIVEZ-VOUS MAINTENANT Earn and redeem with our 200+ retail partners on your holiday purchases. Accumulez et échangez des points pour vos achats des Fêtes auprès de plus de 200 détaillants partenaires. ® Aeroplan is a registered trademark of Aeroplan Inc., used under licence. ®The Air Canada maple leaf logo is a registered trademark of Air Canada, used under licence. Starbucks and the Starbucks logos are registered trademarks of Starbucks Corporation. MD Aéroplan est une marque déposée d’Aeroplan Inc., utilisée sous licence. MD Le logo de la feuille d’érable d’Air Canada est une marque déposée d’Air Canada, utilisée sous licence. Starbucks et les logos de Starbucks sont des marques déposées de Starbucks Corporation. EARN REDEEM & BE MERRY ACCUMULEZ ÉCHANGEZ ET CÉLÉBREZ
A Sustainable Course Un service durable
The November edition of enRoute has long been the most popular, featuring Air Canada’s annual Canada’s Best New Restaurants. Each year, for 21 years, we have sought out and sampled the top new eateries across Canada and compiled a delectable list for readers and foodies.
For the restaurants involved, many small and still getting established, the program brings national publicity – and a welcome boost. We are pleased to help them, and the communities where they are located, as an expression of our greater commitment to corporate sustainability.
At the grassroots level, we have the Air Canada Foundation, now celebrating its tenth anniversary. With its focus on children, the Foundation supported 162 Canadian charities in 2021 and 337 hospital transportation flights – almost one a day – to take children for medical care. The Foundation is also active in food security, with school breakfast programs, and through other initiatives to promote the health, well-being and development of children locally and nationally.
Air Canada’s expansive sustainability strategy also ranges over our governance and procurement practices, our extensive efforts to keep our customers, employees and communities safe, and other programs from humanitarian relief to preserving biodiversity. Such environmental, social and governance considerations are essential for any business to succeed, and we incorporate them into every decision.
Nowhere is this more evident than with the environment. Early this year, we set an ambitious goal of net-zero emissions by 2050. And we included a plan to achieve these targets with new, efficient aircraft, by supporting the development of sustainable fuels, investing in carbon capture, electrifying ground vehicles, and through conservation and recycling.
To engage customers in sustainability at Air Canada, we regularly report on our activities, which also maintains the momentum. I invite you to visit www.aircanada.com, where we have posted our 2021 Citizens of the World sustainability report and the Air Canada Foundation Impact report, as well as our new Task Force on Climate-related Financial Disclosures report.
Le numéro de novembre d’enRoute est toujours très attendu, car il contient le palmarès des meilleurs nouveaux restaurants du Canada selon Air Canada. Cela fait 21 ans que nous recensons et essayons la crème des tables au pays pour proposer une liste sélecte aux lecteurs et gourmets.
Le programme apporte à ces restaurants, souvent petits et à leurs débuts, une publicité nationale et un coup de pouce bienvenu. Nous sommes ravis de les aider, eux et leur localité, puisque cela exprime notre engagement plus vaste à l’égard du développement durable.
Côté bienfaisance, la Fondation Air Canada célèbre ses 10 ans. Vouée aux enfants, elle a soutenu 162 organismes canadiens en 2021 et 337 vols de transport hospitalier - presque un par jour - pour que des enfants puissent recevoir des soins. Elle a aussi à cœur la sécurité alimentaire, avec des programmes de petits-déjeuners dans les écoles et soutient des initiatives visant à promouvoir la santé, le bien-être et l’épanouissement des enfants au niveau local et à l’échelle nationale.
La vaste stratégie d’Air Canada couvre nos pratiques de gouvernance et d’approvisionnement, nos efforts considérables pour assurer la sécurité de nos clients, employés et collectivités, et d’autres programmes allant de l’aide humanitaire à la préservation de la biodiversité. Ces considérations environnementales, sociales et de gouvernance (ESG), essentielles à la réussite de toute entreprise, font partie de chacune de nos décisions.
C’est manifeste sur le plan environnemental. Nous avons adopté cette année un ambitieux objectif de carboneutralité d’ici 2050. Notre plan : avions nouveaux et efficients, soutien au développement et à l’utilisation de carburants durables, investissements dans le captage de carbone, électrification des véhicules au sol, conservation et recyclage.
Pour sensibiliser nos clients, nous rendons compte de nos activités, ce qui maintient notre élan. Je vous invite à découvrir, à aircanada.com, notre rapport de développement durable Citoyens du monde de 2021, le rapport d’impact de la Fondation Air Canada et le nouveau rapport du Groupe de travail sur l’information financière reliée aux changements climatiques.
Michael Rousseau
 President and Chief Executive Officer Président et chef de la direction
President and Chief Executive Officer Président et chef de la direction
If you would like to join Air Canada’s winning team, go to careers.aircanada.com. Si vous voulez vous joindre à l’équipe gagnante d’Air Canada, visitez carrieres.aircanada.com.
Air Canada is committed to offering service in both English and French. For any comment or question regarding our official languages service, go to aircanada.com/ officiallanguages or contact us at ollo@aircanada.ca.
Air Canada s’engage à vous servir en français et en anglais. Pour tout commentaire ou toute question concernant notre service dans les langues officielles, visitez aircanada.com/ languesofficielles ou écrivez-nous à ollo@aircanada.ca.
15LETTER FROM AIR CANADALE BILLET D’AIR CANADA
We’ve added sparkles.
New bubbles. Same crisp, refreshing taste. Pair your next culinary adventure with Evian Sparkling to elevate every bite. Official Water Sponsor of Canada’s Best New Restaurants.
evian is pure and natural as all natural mineral water. Now in a new version with added sparkles.

Take Off — Envol
This year marks the return of the Canada’s Best New Restaurants Top 10 list and we’re still flying high from our whirlwind search for the country’s tastiest spots. Can you blame us? It’s hard to come down from the extraterrestrial dishes and infectious team spirit we found at places like Major Tom, which serves up steakhouse glam 40 floors above Calgary. Cette année marque le retour de notre palmarès des 10 Meilleurs nouveaux restos canadiens, et nous sommes toujours au septième ciel après notre étourdissante quête des plus alléchantes prestations du pays. Vous savez bien : il est dur de toucher Terre après avoir goûté des plats extraterrestres et l’esprit d’équipe contagieux que dégagent certains restos, comme le Major Tom, un steakhouse glamour sis au 40e étage d’un immeuble de Calgary.

TRIPS, TIPS & TRAVEL TRENDSETTERS TUYAUX ET TENDANCES EN VOYAGE
GOING UP ATTEINDRE LE SOMMET
PHOTO: VIRGINIE GOSSELIN


Star brewed for that refreshing first sip. Available on board your Air Canada flight.
Jessica Rosval Shows Us Around nous guide à Modena
Modène
By some miracle, Jessica Rosval nabbed a table at Modena’s famed Osteria Francescana seven days after landing in Italy in 2013 – just in time for her 28th birthday. Chef Massimo Bottura was serving a 12-course tasting menu and, dish by dish, the Canadian chef was swept away. “At the end of dinner, I knew my future was in Modena,” Rosval says. She cancelled the rest of her trip and persuaded Bottura to take her on at the three-Michelin-starred restaurant. The lifealtering meal led to her eventual appointment as head chef at Casa Maria Luigia, where her mastery of Modenese cuisine has earned wide acclaim. As Bottura proclaims, in Modena, slow food and fast cars reign, and Rosval couldn’t agree more. “It’s a city full of contrasts, from aged prosciutto and Parmigiano-Reggiano to ultra-new Ferraris and Ducatis.”
Par miracle, Jessica Rosval a réussi à obtenir une table à la célèbre Osteria Francescana de Modène sept jours après son arrivée en Italie en 2013, juste à temps pour ses 28 ans. Le chef Massimo Bottura servait un menu dégustation de 12 services qui a séduit la cheffe canadienne, un plat à la fois.

« Après le repas, je savais que ma place était à Modène », résume celle-ci. Elle a annulé le reste de son voyage et convaincu M. Bottura de l’en gager à son resto trois étoiles au Michelin. Ce festin déterminant allait l’amener à décrocher le poste de cheffe à la Casa Maria Luigia, où sa maîtrise de la cuisine modénaise a reçu maints éloges. Selon M. Bottura, écogastronomie et bolides sont maîtres à Modène, et M me Rosval acquiesce : « C’est une ville de contrastes, entre prosciutto et parmigiano reggiano vieillis et rutilantes Ferrari et Ducati.

FLR Economy seats to Florence from 38,600 points Places en classe économique à partir de 38 600 points
D’ IRENE RINALDI
ILLUSTRATION BY
PAR KATIE SEHL
BY
19IN TOWNEN VILLE
»
—
PHOTO: STEFANO SCATÀ. POINTS DISPLAYED ARE ESTIMATED RANGES FOR ONE-WAY TRAVEL AND ARE FOR INFORMATIONAL PURPOSES ONLY / SEUIL MINIMAL DE POINTS AÉROPLAN FOURNI À TITRE INDICATIF SEULEMENT, ESTIMÉ SUR LA BASE D’UN ALLER SIMPLE
01 FRANCESCHETTA58
The menu at this Osteria Francescanafamily gastro bistro always changes, as the ingredients vary with the seasons. I usually pop in on Monday evenings for favourites like the risotto with smoked eel from Po River. The smoky flavours mixed with sharp horseradish remind me of home. Le menu de ce bistro gastronomique de la famille de l’Osteria Francescana change au gré des ingrédients de saison. J’y vais généralement le lundi soir pour goûter à mes plats favoris, comme le risotto avec anguille fumée du Pô. Le fumé mêlé au piquant du raifort me rappelle la maison.
FRANCESCHETTA.IT
02 ROOTS
I co-founded this non-profit restaurant and social project as a culinary training program for migrant women in our community. We invite diners to discover the beautiful diversity of Modena through a menu flavoured by the origins of our trainees. J’ai cofondé ce resto sans but lucratif et projet social pour offrir des ateliers de cuisine aux femmes migrantes de la collectivité. On invite le public à découvrir la belle diversité de Modène grâce à un menu influencé par les origines des participantes.

JESSICA’S 5 SPOTS
LES 5 ADRESSES DE JESSICA
03 COTTON CLUB SPEAKEASY

Every Sunday night there’s a different band playing mostly jazz or blues here. There is a very “speakeasy” vibe to the place and the crowd is more mature – made up of people who enjoy a quality cocktail and great music. Tous les dimanches soir, des musiciens se produisent sur scène, jouant surtout du jazz et du blues. Dans ce repaire feutré, la clientèle est plus mûre et composée de gens qui aiment les bons cocktails et la bonne musique.
COTTONCLUB-MO.IT
04 PARCO GIARDINO
DUCALE ESTENSE
Summers in Modena are very hot and there is ample shade here to relax and picnic with friends. I love visiting in the afternoons on my days off. The Palazzina Vigarani often hosts art and historical exhibitions as well.

L’été est très chaud à Modène et ce parc procure beaucoup d’ombre où se relaxer et piqueniquer entre amis. J’aime y aller l’après-midi quand je suis en congé. La Palazzina Vigarani accueille souvent des expos d’art et d’histoire.
MODENAPARCHI.COM/MODENA-PARCODUCALE-ESTENSE
ANTICA OSTERIA DEL MIRASOLE
This rustic restaurant is dedicated to protecting and perfecting time-honoured Modenese recipes.


It’s so important to have a deep respect for history and tradition before trying experimental cuisine.
Ce resto rustique s’emploie à sauvegarder et à parfaire les recettes modénaises classiques.
Il est essentiel d’honorer l’histoire et les traditions avant de se lancer dans la cuisine expérimentale.
OSTERIADELMIRASOLE.IT
EN VILLEIN TOWN20
ROOTSMODENA.COM
PHOTOS: GIOVANNI HABIB, MICHELE ERCOLANI (01); GLORIA SOVERINI (02); FRANCESCO MORELLI (04); ALBERTO BLASETTI (05).
ILLUSTRATION: IRENE RINALDI.










15 4 2 6 8 12 17 1 5 16 14 21 20
SHAYMA
PAR RONKE EDOHO, JON KUNG
BY

Shayma Saadat, Ronke Edoho & Jon Kung
Three content creators discuss why “authenticity” has become a bad word in the food world, and why “fusion” doesn’t have to be.


Trois créateurs de contenu parlent de l’« authenticité » comme d’un concept dépassé en gastronomie et des bienfaits de la fusion.
If you’ve scrolled down Instagram’s recipe rabbit hole, chances are you’ve come across Jon Kung’s Spice Library Chronicles, Ronke Edoho’s Nigerian meal inspiration or Shayma Owaise Saadat’s famous strawberry chaat. To try one of their recipes is to follow in their footsteps, but the path is almost never a straight line. Raised between North York and Hong Kong, Kung bounced around restaurants in Detroit before launching one of the city’s first pop-up series and secret dinner parties. When the pandemic hit, he switched to cooking for the Internet. After moving from Lagos to Saskatoon, cookbook author and certified nutritionist Edoho made the leap to Instagram via her blog 9jafoodie, where she shares healthy spins on traditional West African recipes. Better known as Spice Spoon, Saadat’s dishes combine the flavours of her Pakistani, Afghan and Persian heritage from her home in Toronto –by way of Bangladesh, Kenya and Italy, among others. The three creators sat down to talk food, identity and reimagined cuisines.
Si vous aimez errer dans les recettes d’Instagram, il y a de fortes chances que vous connaissiez Spice Library Chronicles de Jon Kung, les mets d’inspiration nigériane de Ronke Edoho et le célèbre chaat aux fraises de Shayma Owaise Saadat. Essayer leurs recettes, c’est suivre leur trajectoire, même si elle est large de détours. Élevé entre North York et Hong Kong, M. Kung a travaillé dans plusieurs restos de Detroit avant de lancer l’une des premières séries de pop-up et de soupers festifs secrets en ville, jusqu’à ce que la pandémie le confine au web. Après avoir quitté Lagos pour Saskatoon, Mme Edoho, auteure de livres de cuisine et nutritionniste certifiée, a fait le saut sur Instagram via son blogue 9jafoodie, qui présente des versions santé de recettes traditionnelles d’Afrique de l’Ouest. Les mets de Mme Saadat, alias Spice Spoon, traduisent son héritage pakistanais, afghan et persan, en passant par le Bangladesh, le Kenya et l’Italie, entre autres, et tout ça, depuis sa demeure à Toronto. Les trois créa teurs nous parlent aliments, identité et cuisine réinventée.
22 LA CONVERSATIONTHE CONVERSATION
AND/ET
OWAISE SAADAT ILLUSTRATIONS BY DE PAUL RYDING
@SpiceSpoon thespicespoon.com
Q. Shayma Saadat
“What does food mean to you beyond what you physically put on the table? How has it shaped your identity?” « Au-delà de ce que vous disposez sur la table, quel rôle joue pour vous la nourriture? Comment a-t-elle façonné votre identité? »
Ronke Edoho: Food, for me, is really about community. Growing up, when my grandmother would cook, food opened the door to an extended family. There would always be kids from the neighbourhood over for supper. When it comes to my food identity, I’m a Nigerian girl who lives in the Canadian Prairies, and that is very reflected in my food. Pour moi, c’est une question de communauté. Quand j’étais petite, les repas cuisinés par ma grand-mère permettaient d’élargir notre famille y avait toujours des enfants des environs qui venaient souper. Pour ce qui est de mon identité culinaire, je suis une Nigériane qui vit dans les Prairies canadiennes, et cela se reflète dans mes créations.
Jon Kung: In the most significant way, food was how I re-established my ethnic Chinese identity. Growing up in the suburbs of Toronto, food was initially a source of shame and embarrassment. Many of us have childhood memories of getting made fun of for bringing “stinky food” to school. Naturally, during those years, I never really celebrated the food I now love so much and depend on for an income.
During my early career as a cook, I was really chasing authenticity. Later on, I realized I was trying to overcompensate for cultural insecurity. I now call my cuisine third-culture food. To me, it means celebrating and owning the fact that I come from two different cultures and I am completely immersed in two cultures. — La cuisine a joué un rôle majeur lorsque j’ai cherché à réaffirmer mon identité chinoise. Durant ma jeunesse en banlieue de Toronto, la nourriture était une source de honte et d’embarras. Plusieurs se souviennent d’avoir subi des moqueries en raison des « repas puants » apportés à l’école. Naturellement, durant ces années, je n’ai jamais vraiment célébré les mets que j’aime tant aujourd’hui et dont je dépends pour gagner ma vie.

Au début de ma carrière de cuisinier, j’étais vraiment en quête d’authenticité. Plus tard, j’ai réalisé que j’essayais de surcompenser mon insécurité culturelle. Je considère désormais ce que je fais comme une cuisine de tierce culture », c’est-à-dire une célébration de mon appartenance et de mon immersion complète dans deux cultures différentes.

Shayma Saadat: I am what I call a multihyphenated Canadian. I’m a Pakistani Afghan with Persian ancestry. Food is very much a reflection of my heritage, and it’s also a reflection of the place that I call home.
I feel very strongly about calling my food Canadian food, even though it’s rooted in my heritage and is multicultural. It’s very important for me to make the claim that Canadian food is not just BeaverTails or things with maple syrup. We are Canadian. And I think it’s important for people to recognize that and view our contributions as part of the Canadian culinary landscape. Je suis une Canadienne aux origines culturelles mul: je suis Afghane et Pakistanaise de descendance persane. Ma nourriture est le reflet de mon patrimoine, mais aussi de l’endroit où je me sens chez moi.
J’ai très envie de qualifier ma cuisine de canadienne, même si elle est enracinée dans mon héritage multiculturel. Je le dis haut et fort : la nourriture canadienne ne se limite pas aux queues de castor ou aux produits contenant du sirop d’érable. Nous sommes Canadiens et Canadiennes, et je trouve important que ce soit reconnu, que nos contributions fassent partie du paysage culinaire canadien.


23THE CONVERSATIONLA CONVERSATION


















You’re a Member when you’ve got the cove to yourself. Learn more at Amex.ca/WhyAmex
@9jaFoodie 9jafoodie.com
Q. Ronke Edoho
JK: The real answer is that I don’t. We have to ask ourselves what people think of when they say Canadian or American. Normally when someone looks at your recipe and says “This will appeal to the majority of Americans,” they generally mean white Americans. La vraie réponse ? Je ne le fais pas. Nous devons réfléchir à ce qu’évoquent chez les gens les mots « « Américain ». Lorsqu’une personne consulte votre recette et dit qu’elle plaira à la plupart des Américains, elle parle généralement des Américains blancs.
RE: But what about ethnic cuisines that are not yet in the mainstream? If you think about food as a cultural export, from countries like Ghana or Zimbabwe, how do you start to have conversations about what is traditional and authentic? And what modifications make it more appealing or international?

If Chinese food was kept traditional – no extra sugar or salt added for Americans, for example – I don’t think it would be as popular as it is now. It’s the same thing with the Jamaican beef patty. The patty that you eat in Toronto is different from the one you eat in Jamaica. How can we be a part of these conversations and help our cuisines have broader appeal without, you know, selling out? des cuisines ethniques qui n’ont pas encore été intégrées à la cuisine dominante dérez que la nourriture est une exportation culturelle, issue du Ghana ou du Zimbabwe, comment déterminer ce qui est traditionnel et authentique ? Qu’est-ce qui rend une recette plus attrayante ou internationale ?
Si la nourriture chinoise restait traditionnelle, sans ajout de sucre ou de sel pour les Américains, par exemple, je ne pense pas qu’elle jouirait d’une aussi grande popularité. Pareil pour les feuilletés jamaïcains au bœuf : ceux que vous mangez à Toronto diffèrent de ceux servis en Jamaïque. Comment pouvons-nous participer à ces discussions et démocratiser davantage nos recettes sans sacrifier leur essence ?


SS: We are already a part of these conversations. The whole idea of authenticity is rubbish to me. When people say “authenticity” they want us to re-enact a scene: a woman sitting in Pakistan making the chapati, the dirty rickshaw, dirty clothes, children playing in the background – those perceptions. Why is it that French and Italian food can transcend these clichés? Why do those of us who are from countries that were economically vulnerable – I hate the label “developing” – have to be authentic when everyone else is allowed to innovate? Nous faisons déjà partie de la conversation. Toute la notion d’authenticité est absurde pour moi. Les gens emploient ce mot dans l’espoir que nous reconstituions une scène : une femme qui prépare le chapati par terre au Pakistan, le rickshaw sale, les vêtements sales, les enfants qui jouent en arrière-plan et tous les autres clichés. Pourquoi les cuisines française et italienne y échappent-elles ? Pourquoi ceux qui viennent de pays économiquement vulnérables – je déteste « en développement » – doivent-ils être authentiques alors que les autres ont le droit d’innover ?

25THE CONVERSATIONLA CONVERSATION
“How do you navigate modifying traditional recipes for broader appeal?” « Comment changez-vous les recettes traditionnelles pour les rendre plus attrayantes ? »
RE: I also think about recipes in terms of ownership. You know, when you google “jollof rice recipe” Jamie Oliver’s recipe is going to be one of the first results you see – and it shouldn’t be. In those situations, I think it’s extremely important to make sure the conversation, recipe definition and ingredients are respectful of traditions. If we are not in the position to write our own food story, or if someone else does, they become the voice of authenticity, and that can really erode the cultural significance of a recipe. Je fais aussi référence à la propriété des recettes. Par exemple, si vous googlez « recette de riz jollof », vous tomberez d’abord sur la version de Jamie Oliver, ce qui ne devrait pas être le cas. Je pense qu’il faut s’assurer que les discussions, les défini tions et les ingrédients des recettes respectent la tradition. Si on ne peut pas écrire notre propre histoire alimentaire, ou si une autre personne le fait à notre place, c’est cette personne qui devient la voix de l’authenticité, ce qui peut éroder la signification culturelle d’une recette.

JK: When it comes to food, especially in cultural contexts, I’ve always thought of authenticity as a very bad word. The only way that I accept authenticity is in terms of a person cooking in a way that feels authentic to them and representative of who they are. Otherwise, authenticity is just a word that people outside of a specific culture use to pretend they have insider knowledge of places like Chinatown. Quand il s’agit de bouffe, surtout en contexte culturel, je pense que « authenticité » est un très mauvais mot. Une personne qui cuisine d’une manière qui lui semble authentique et représentative de qui elle est, ça, pour moi, c’est de l’authenticité. Sinon, ce n’est qu’un mot galvaudé par ceux qui prétendent bien connaître une culture sans en faire partie, comme on le voit avec les quartiers chinois.
SS: I also absolutely respect what Ronke was saying. For people like us, there will always be that push and pull between preservation and innovation. There are always going to be purists, and I respect that. But personally, I don’t want to have to follow a perceived idea and taste of authenticity because I feel that it stifles my sense of creativity and my sense of self. Je suis parfaitement d’accord avec Ronke. Pour nous, il y aura toujours ce tiraillement entre la préservation et l’innovation. Il y aura toujours des puristes aussi. Mais je ne souhaite pas me laisser guider par ce que les autres perçoivent comme un goût authentique : j’ai l’impression que ça étouffe ma créativité et la perception que j’ai de moi-même.
Q. Jon Kung

“Do you think the diaspora can be its own unique community and culture?” « La diaspora peut-elle constituer une communauté ou une culture unique en son genre ? »
RE: I’m inclined to say yes. When you move or when you are born into a new culture, whether you’re second-, third-, or fourth-generation, you still identify with the culture the diaspora comes from. But you also create your own cultures and rituals around food and how you cook, and use ingredients that are locally available. J’aurais tendance à dire oui. Lorsqu’on déménage ou qu’on naît dans une nouvelle culture, peu importe la génération d’immigration, on s’identifie toujours à la culture dont la diaspora est issue. Mais on crée aussi nos propres cultures et rituels autour de la cuisine, tout en utilisant les ingrédients offerts sur place.
26 LA CONVERSATIONTHE CONVERSATION
“When it comes to food, especially in cultural contexts, I’ve always thought of authenticity as a very bad word.” — « Quand il s’agit de bouffe, surtout en contexte culturel, je pense que "authenticité" est un très mauvais mot. »
@ChefJonKung beacons.ai/chefjonkung
Dig into inspiring stories and mouthwatering recipes discovered over two decades of Canada’s Best New Restaurants. Learn more at canadasbestnewcookbook.ca.



Goûter les savoureuses histoires et recettes dénichées depuis plus de 20 ans dans le cadre des Meilleurs nouveaux restos canadiens. Pour en savoir plus, rendez-vous à livredecuisinecanadien.com.





Each copy sold supports future hospitality professionals.



Chaque livre vendu soutient les futurs professionnels du milieu de l’hospitalité.
Available now
En vente dès maintenant

Air Canada enRoute � Destination Canada
SS: I think of it in terms of the diaspora being unique. For those of us who migrated from the country of our birth, our food is a reflection of those movements and those journeys to new homes. The flavours of my childhood, while they’re influenced by my heritage, are also a confluence of the pantries and the landscapes of the countries I grew up in. La diaspora est unique. Pour ceux d’entre nous qui avons quitté notre pays de naissance, notre cuisine est le reflet de ces mouvements et de ces voyages vers de nou veaux chez-soi. Les saveurs de mon enfance, bien qu’elles soient influencées par mon héritage, sont aussi une confluence des garde-manger et des pay sages des autres pays où j’ai grandi.


I think people within all diasporas share similarities and experiences that connect us in ways that even our cousins back home can’t relate to. That is actually one of the strongest qualities of our experience, and I think it has the greatest potential in the way it informs our cooking.
It’s not just the westernization of our cuisine. It’s the extreme diversification of our cuisine. It’s taking advantage of our close proximity to each other in ways that aren’t possible back home and in ways that can only happen here. That’s what the future of Canadian and American food can be. Je pense que les membres de toutes les diasporas sont reliés par des expériences similaires que même nos cousins restés au pays ne peuvent pas comprendre. C’est l’une des plus grandes qualités de notre expérience, et je crois qu’elle a un immense potentiel quant à son influence sur notre cuisine.
Il ne s’agit pas seulement de l’occidentalisation de notre cuisine, mais plutôt de son extrême diversification. Il faut tirer profit de notre proximité les uns des autres, d’une manière qui est impossible chez nous et qui ne peut se produire qu’ici. C’est peut-être ça, l’avenir de la cuisine canadienne et américaine.
SS: Yes, reimagined food. Reimagined cuisines. Oui, une nourriture et des cuisines réimaginées.
RE: I completely agree. There’s an opportunity here for us to learn from each other and create a new world of food. Tout à fait d’accord. C’est une belle occasion d’apprendre les uns des autres et de créer un nouveau monde culinaire.
Read more of the conversation at Lisez plus de la conversation sur ENROUTE.AIRCANADA.COM
LA CONVERSATION
“For those of us who migrated from the country of our birth, our food is a reflection of those move ments.” — « Pour ceux d’entre nous qui avons quitté notre pays de naissance, notre cuisine est le reflet de ces mouvements. »

PLEASE
ENJOY RESPONSIBLY.

Drink responsibly Buvez avec modération PRESENTS PRÉSENTE The Art of Perfect Cocktail Pairing L’art du mariage parfait des cocktails 01 02 03 30 AIR CANADA ENROUTE × DIAGEO
Raise a Glass to the Top 3! Trinquez à la santé des 3 finalistes !
Shake up your hosting or toasting skills with one-of-a-kind cocktail recipes created by Diageo World Class bartender James Grant, each one inspired by the flavours, dishes and cuisines of the Top 3 Canada’s Best New Restaurants 2022. Rehaussez d'un cran vos réceptions grâce à ces délices inédits signés par le créateur de cocktails James Grant, lauréat du Diageo World Class, inspirés des saveurs, plats et types de cuisine des trois finalistes des Meilleurs nouveaux restos canadiens 2022.
PHOTOS: ASHLEY VAN DER LAAN (PHOTOGRAPHER/PHOTOGRAPHE); RENÉE DREXLER (STYLIST/STYLISTE) (COCKTAILS); SUPPLIED BY/FOURNIE PAR JAMES GRANT (PORTRAIT).

01 Green Ribbon Le ruban vert
1 oz Tanqueray
No. Ten Gin
½ oz olive oil-washed fino sherry*
½ oz Seedlip Garden 108
½ oz snap pea and lovage cordial*
2 oz sparkling mineral water
Halved snap pea
1 oz de gin Tanqueray No. Ten
½ oz de xérès fino aromatisé à l’huile d’olive*
½ oz de Seedlip Garden 108
½ oz de cordial aromatisé aux pois mange-tout et à la livèche*
2 oz d’eau minérale pétillante
1 demi-pois mange-tout
02 Night Moves La virée nocturne
1 ¾ oz Johnnie Walker Black Label
½ oz candy cap and pear maple syrup*
¼ oz verjus
¾ oz Oloroso sherry 2 dashes of Angostura bitters Brandied cherry
1 ¾ oz de whisky Johnnie Walker Black Label
½ oz de sirop d'érable infusé aux champignons candy cap et à la poire*
¼ oz de verjus
¾ oz de xérès oloroso
2 traits d’amer Angostura
1 cerise à l’eau-de-vie
03 Neon Tiger Le tigre néon
2 oz Don Julio Reposado
½ oz pink peppercorn and lemongrass honey*
1 oz lime juice
½ oz yuzu liqueur 1 lime wedge Togarashi salt
2 oz de tequlia Don Julio Reposado
½ oz de miel aromatisé au poivre rose et à la citronnelle*
1 oz de jus de lime
½ oz de liqueur de yuzu
1 quartier de lime
Sel togarashi
Starting with Tanqueray No. Ten Gin, layer the ingredients in a Collins glass. Add olive oil-washed fino sherry followed by Seedlip Garden 108 and snap pea and lovage cordial. Give everything a stir, then add ice and sparkling water. For the garnish, cut a snap pea in half and rest it on top, or pin it with a cocktail pick. Dans un verre Collins, verser l’un après l’autre les ingrédients, en commençant par le gin Tanqueray No. Ten. Bien mélanger, puis ajouter des glaçons et l’eau pétillante. Coiffer du pois mange-tout ou l’embrocher sur un cure-dent à cocktail.
Pairs with light vegetable and fish flavours. Secondary notes of rich dairy. S'accorde avec des légumes ou du poisson au goût délicat. Notes secondaires de crème.
Pour Johnnie Walker Black Label and candy cap and pear maple syrup into a mixing glass. Add verjus and Oloroso sherry, then balance it off with two dashes of Angostura bitters. Mix in ice and stir. Strain the mixture into a chilled Nick & Nora glass, and top it off with a brandied cherry on a cocktail pick. Dans un verre mélangeur, verser le Johnnie Walker Black Label et le sirop. Ajouter le verjus et le xérès, puis équilibrer avec 2 traits d’amer. Ajouter des glaçons et mélanger. Passer au tamis dans un verre Nick & Nora refroidi, puis coiffer de la cerise à l’eau-de-vie piquée sur un cure-dent à cocktail.
Pairs with rich, autumnal flavours. Earthy, smoky, sweet and tart. S'accorde avec de riches saveurs automnales. Terreux, fumé, sucré et acidulé.
In a shaker, add Don Julio Reposado and pink peppercorn and lemongrass honey, followed by lime juice and yuzu liqueur for a zing of acidity. Give it a shake. Run a lime wedge around the rim of a rocks glass, then roll the rim in togarashi salt. Add a few ice rocks and strain your mixture on top. Dans un shaker, verser le Don Julio Reposado et le miel, puis le jus de lime et la liqueur de yuzu, pour une pointe d’acidité. Bien mélanger. Passer un quartier de lime sur le rebord d’un verre Rocks, puis rouler le rebord dans le sel togarashi. Mettre des glaçons dans le verre et y verser le cocktail en le filtrant.
Pairs with umami, spice and bright herbaceous notes. S'accorde avec des notes umami, épicées ou herbacées.
*WATCH THE VIDEOS AND FIND MORE RECIPE DETAILS AT CanadasBestNewRestaurants.com *REGARDEZ LES VIDÉOS ET TROUVEZ PLUS DE DÉTAILS SUR LES RECETTES À LesMeilleursNouveauxRestosCanadiens.com
31AIR CANADA ENROUTE × DIAGEO
 BY PAR NANCY MATSUMOTO PHOTOS BY DE VIRGINIE GOSSELIN
BY PAR NANCY MATSUMOTO PHOTOS BY DE VIRGINIE GOSSELIN
We’re calling it a comeback. Not only because our anonymous food critic reprised her culinary marathon, landing in no fewer than 17 cities to taste-test menus at the most tantalizing restaurant openings across the country (polishing off 226 dishes along the way). Or because our Top 10 list is back by popular demand. We’re talking about the revivals and reinventions that burst onto the dining scene this year, from a Vietnamese offshoot splashing up pho with canoe-cut bone marrow to reshuffled dream teams coaxing us to make up for lost meals with herbaceous tasting menus. The joy of eating out is back, and – dare we say – more delectable than ever.
Nous appelons ça tout un retour. Pas seulement parce que notre critique gastronomique anonyme s’est posée dans pas moins de 17 villes pour goûter les menus de nouveaux venus parmi les plus alléchants du pays (226 plats savourés au passage). Ni parce que notre palmarès est de retour, à la demande générale. Nous parlons de retour, car nous avons assisté à des renaissances et à des réinventions qui ont fait bouillonner la scène gastronomique 2022, qu’on parle d’un resto vietnamien servant des phôs avec os à moelle présentés en canoë ou de brigades de rêve proposant des plaisirs herbacés. La joie de se restaurer est de retour et, n’ayons pas peur des mots, est plus exquise que jamais.
Restaurant 20 Victoria
ur trout is from Affinity Fish in Toronto and our swordfish is from Organic Ocean in B.C.; it’s fully traceable,” our cheerful, aproned server tells us when we grill her about our first two dishes. Composed of just a few ingredients, their magic has left us walleyed with wonder: a silky, vegetal swordfish and caraway crudo with fennel and an almond-sherry vinegar sauce, and a restrained, delicately steamed trout dish with radishes, crème fraîche and pink grapefruit. Because she’s so humble and preternaturally sunny, it takes us a few moments to catch on: We’re speaking to head chef Julie Hyde.
If you haven’t heard of her – she slipped off to hone her talent in the three-Michelin-starred kitchens Maison Lameloise in Burgundy and London’s Alain Ducasse at The Dorchester – the Scarborough, Ontario-raised starin-the-making leads the kitchen at the much-anticipated successor to Brothers Food & Wine (No. 8, CBNR 2017). Here floor-to-ceiling draperies, herringbone parquet floors and crisp white linens fancy up the old Imperial Life Building. The upfront bar area is for à la carte plates, and the dining room and patio for the six-course tasting menu (with optional wine pairings and add-ons).
The staff is lean and non-hierarchical: Hyde and sous chef Jenna Reich serve as well as tend the kitchen, making short trips between the front and back. This is performance, everyone acknowledges: “We hired really experienced cooks who are comfortable working in the open,” Hyde explains. Yet host and partner Christopher White, usually found patrolling the floor, is nowhere to be seen; the dishwasher called in sick tonight so he’s in back, scrubbing.
ffinity Fish, à Toronto, pour la truite, et Organic Ocean, en Colombie-Britannique, pour l’espadon ; la traçabilité est totale », lance notre joviale serveuse en tablier quand nous la cuisinons sur nos deux premiers plats. Avec trois fois rien, le crudo d’espadon au carvi, végétal avec son fenouil et sa sauce au vinaigre de xérès et aux amandes, et la délicate et sobre truite vapeur, avec radis, crème fraîche et pamplemousse rose, font mouche : nous mordons goulûment à l’hameçon. Comme elle est à la fois humble et super radieuse, il nous faut un petit moment pour allumer : la fille devant nous est la cheffe, Julie Hyde.




Si vous l’ignoriez – elle affinait ses talents dans les cuisines trois étoiles au Michelin de la Maison Lameloise, en Bourgogne, et d’Alain Ducasse at The Dorchester, à Londres –, cette future star originaire de Scarborough, en Ontario, dirige la cuisine du successeur tant attendu du Brothers Food & Wine (notre no 8 en 2017). Ici, rideaux pleine hauteur, parquet à bâtons rompus et linge blanc éclatant ornent le vieil édifice de l’Imperial Life. Au bar à l’entrée, on sert des plats à la carte ; en salle et en terrasse, des menus dégustation de six services (avec accords mets-vins et suppléments en option).
L’équipe est réduite et la hiérarchie inexistante : au four et au moulin, cheffe et sous-cheffe (Jenna Reich) font de brefs allers-retours entre salle et cuisine. Du spectacle, tout le monde en convient. « Nous avons engagé des cui siniers d’expérience qui ne rechignent pas à travailler en aire ouverte », explique Mme Hyde. Pourtant, l’hôte et associé Christopher White, qui d’ordinaire veille au grain en salle, est aux abonnés absents : un plongeur étant malade, il récure en cuisine.
34
TORONTO INSTAGRAM.COM/TWENTYVICTORIA
01
“0 «A
OPENING PAGE EN OUVERTURE
Một Tô’s Bun Rieu, crab and pork tomato rice noodle soup, leaves diners smiling and coming back pho more.
Le bun rieu de Một Tô, soupe de nouilles de riz tomate-crabe-porc, ravit les clients, qui se disent « phô revenir ».
It’s a front- and-back-ofhouse team effort at this Victoria Street gem, where elegant dishes with bright vegetal notes read like love letters to Ontario growers.


C’est un travail d’équipe cuisine-salle à manger qui a cours dans ce joyau de la rue Victoria, où les chics plats aux vives notes végétales sont une ode aux producteurs ontariens.

35
Guests are readied for the catch of the day: halibut and eggplant-stuffed zucchini blossom resting in a carrot and white vermouth sauce. La prise du jour au menu des convives : flétan et fleur de courgette farcie à l’aubergine sur sauce carotte et vermouth blanc.


Floor manager Danna Oleynikov tells us a little story about every wine pairing she introduces from a pulsating, all-winners list put together by sommelier Toni Weber. The bone-dry fruity and mineral-driven biodynamic Domaine Trapet riesling was born when the Alsatian wife of a revered Burgundy winemaker wanted to try his methods on her home turf. Like the restaurant itself, it’s restrained yet electrically charged, cutting like a jewelled knife through the richness of the rustic “nonna soufflé,” the creamy flan-like sformato surrounded by lightly buttered al dente peas and topped with sturgeon caviar.
Across the room, a lovestruck couple and the trio of friends next to them are taking turns snapping photos of each other, while a pair of pearl-and-Chanel-wearing ladies take their check. Reich presents us with her salted, honeyed and herbal lemon semifreddo. Here, too, the building blocks are simple – partly, Reich says, out of necessity: “I don’t have an ice cream maker.” So, she’s blended sugar, eggs and whipped cream with whole preserved lemons to make something so mouth-puckering it barely qualifies as dessert. Yet the result – like everything at this best new restaurant in Canada – is brilliant.
La cheffe de salle, Danna Oleynikov, a une anecdote à raconter pour chaque cru accompagnant notre repas qu’elle puise à la palpitante carte des vins de la sommelière Toni Weber. Le riesling biodynamique du domaine Trapet, au fruité sec et minéral, est né quand la conjointe alsacienne d’un vigneron bourguignon renommé a décidé d’appliquer les méthodes de ce dernier à son terroir à elle. À l’image du restaurant, il est tout en retenue, mais électrisant, tranchant brillamment avec le gras du rus tique « soufflé de la grand-mère », un sformato (flan) crémeux coiffé de caviar d’esturgeon et servi avec des petits pois al dente revenus dans un peu de beurre.
À l’autre bout de la salle, un couple d’amoureux et le trio d’amis à ses côtés se photographient à qui mieux mieux, alors que deux dames portant perles et Chanel demandent l’addition. M me Reich nous présente un semifreddo salé-sucré (au miel), citronné et rehaussé de fines herbes. Là encore, la composition est simple, en partie, confie-t-elle, par nécessité (« je n’ai pas de sorbetière »). Elle a donc mélangé sucre, œufs et crème fouettée avec des citrons confits entiers et créé un plat si vivifiant que c’est à peine un dessert. Le résultat, comme tout au menu de ce meilleur nouveau restaurant canadien, est remarquable.
RESTAURANT 20 VICTORIA DESSERT OF THE YEAR DESSERT DE L’ANNÉE
de
Pâté à bombe mixed with a lemon purée Pâte à bombe mélangée à une purée de citron
:

Salted Lemon Semifreddo: cream, eggs, sugar, puréed salted lemons, honey and olive oil. Le semifreddo au citron salé
crème, œufs, sucre, purée
citrons salés, miel, huile d’olive. 37
Sweet wildflower honey verjus Verjus au miel de fleurs sauvages
Mastard

38 MONTRÉAL RESTAURANTMASTARD.COM 02
Like the shy kid who doesn’t want to attract too much attention to himself, the place we’re looking for is modestly tucked away in the family-friendly neighbourhood of Rosemont. But once we make our way through a pair of aluminum doors under a black sign bearing eleven spindly conifers, we’re walloped by the plaintive, powerful voice of Sharon Jones and her Dap-Kings on “How Long Do I Have to Wait for You?”
They’re calling us home to chef Simon Mathys’ first solo business venture, a warm room with teal-green walls, pressed-tin ceiling, utilitarian leather banquettes and brass-tack-covered chairs. There’s a generosity of spirit here too, in the way Mathys gives a shout-out on his menu to his entire staff, including his wife and co-owner, Viki Brisson-Sylvestre, “without whom none of this would be possible,” he notes.
The first course of our optional tasting menu –bright green peas blanched in their own juices, garnished with camomile petals and thin triangles of lemon over camomile flan – confirms our hunch that there’s something extraordinary going on here. Mathys is speaking the same gastronomic language that won him acclaim at restaurants Manitoba and Racines: poetic homages to the food of his native Quebec. But here his sentences ring with the bold confidence of
Tenseigne noire affichant onze frêles conifères, nous sommes sonnés par la voix puissante et plaintive de Sharon Jones qui, avec ses Dap-Kings, chante : How Long Do I Have to Wait for You?.
C’est ainsi qu’on nous accueille au premier resto solo du chef Simon Mathys, à la salle à manger chaleureuse avec murs sarcelle, plafond de tôle embossée, banquettes de cuir rectilignes et chaises capitonnées. Une grandeur d’âme habite aussi l’endroit ; au menu, par exemple, où le chef remercie toute son équipe, notamment sa femme et copropriétaire, Viki Brisson-Sylvestre, « sans qui rien de tout cela ne serait possible ».
Le premier service de notre menu carte blanche – pe tits pois luisants blanchis dans leur jus, garnis de pétales de camomille et de minces triangles de citron sur flan à la camomille – confirme notre intuition : il se joue quelque chose d’extraordinaire ici. M. Mathys parle bien la langue gastronomique qui lui a valu des éloges aux restaurants Manitoba et Racines : une poésie qui rend hommage aux produits de son Québec natal. Mais, ici, ses vers riment avec la confiance hardie de celui qui est vraiment de retour à la maison.
Herbal emulsions and marigold colour dishes like Gaspésie Arctic char and grilled zucchini. Émulsions herbacées et plats colorés à la fleur de souci (omble chevalier gaspésien et courgettes grillées).

Chef Simon Mathys’ abode is an ode to terroir, from ripe strawberry soup to abstract landscape murals inspired by the Quebec Plasticien art movement.
La maison du chef Simon Mathys célèbre le terroir et la province, de la soupe de fraises mûres aux murales abstraites inspirées des Plasticiens.

Drizzled to perfection: A plate of raw scallops, white turnips and chanterelles in a green pea emulsion. Nappage parfait : assiette de pétoncles crus, navets blancs et chanterelles, dans une émulsion aux petits pois.

someone who has truly come home.
We swoon over a fat, ruby-red slice of La Ferme des Quatre-Temps tomato sprinkled with herbs and flowers and resting on a vivid green-gold slick of camelina oil. Our server pours over it a small pitcher of hot, fragrant smoked beef fat to complete a haunting ode to field and farm that deserves to be set to music. The fruity Cante Gau carignan blend from Domaine de La Réaltière (a biodynamic Provence wine from an international list selected by sommelier Joannie Lévesque) is the final flourish in a resounding chorus. That’s what makes a meal at Mastard so complete and satisfying: You can’t tell the background singers from the lead.
Nous voici en pâmoison devant une grosse tranche de tomate rubis de la Ferme des Quatre-Temps garnie de fines herbes et de fleurs et reposant sur l’or verdi d’une huile de caméline. En l’arrosant de graisse de bœuf fumée chaude, notre serveur parachève cette ode envoûtante aux champs et à la ferme qui mériterait qu’on la mette en musique. Le Cante Gau fruité, un assemblage de carignan du domaine de La Réaltière (un vin biodynamique provençal qu’avec d’autres crus de pays divers la sommelière Joannie Lévesque a choisi pour sa carte), est la dernière fioriture d’un hymne retentissant. C’est ce qui fait d’un repas au Mastard une expérience si complète et si satis faisante : la voix et le chœur y chantent à l’unisson.
Mathys catches up with Pauline Guérin at the Jardin des Filles à Paul stall on his morning run to Jean-Talon market. Le chef Mathys papote avec Pauline Guérin à l’étal du Jardin des Filles à Paul, au marché Jean-Talon, lors de ses courses matinales.

40
Heirloom tomato from La Ferme des Quatre-Temps Tomate de variété ancienne de la Ferme des Quatre-Temps
MASTARD
DISH OF THE YEAR PLAT DE L’ANNÉE

Camelina oil and smoked beef fat Huile de caméline et graisse de bœuf fumée
A bouquet of herbs and edible flowers Bouquet de fines herbes et de fleurs comestibles
La Ferme des Quatre-Temps Tomato: herbs, lettuce, flowers, camelina oil and smoked beef fat.
La tomate de la Ferme des QuatreTemps : fines herbes, laitue, fleurs, huile de caméline, graisse de bœuf fumée.
Mimi Chinese
urrounded by plush red banquettes and gorgeous white lotus wallpaper with a slightly noir underbelly, our black tabletop glows like a spotlit stage. Then the show begins. Holding a small pair of silver tongs, our bow-tied server ceremoniously removes the cucumber garnish from atop a pile of four-foot-long Shaanxi belt noodles, then lifts one fat ribbon high in the air to show off its nubbly, chili-oil and mushroom-slicked surface, before snipping the set down to size with a pair of filigreed gold scissors. Our mouths water like Pavlov’s Northern Chinese dog.
The glamorous room and the showy service are a nod to the theatrical, old-school steakhouses of Miami or Hollywood, and tailor-made for the Yorkville jet set. Yet clues to Mimi’s much more rustic culinary heart are hidden in the washroom anteroom, where a black-andwhite photo of a grizzled food market hawker, taken by chef David Schwartz on a trip to Chengdu, hangs above a black lacquer chest inlaid with mother-of-pearl.
The magic of Mimi – led by the same team that brought us the smash pandemic takeout hit Sunnys Chinese (2021 winner) – is in the way it channels the soul of such humble cooks and the regional cuisines they represent. The transmutation that follows results in polished, peerless dishes that hew to tradition yet deliver the shock of the new. Cabbage is cooked in a stone oven with cumin oil, Szechuan peppercorns and sweet soy, wearing a char that evokes toasted marshmallows. A
D
ans un décor de banquettes rouges cossues et de papier peint à lotus blancs éclairé, par le bas, à la manière d’un film noir, notre table ébène luit comme dans le halo d’un projecteur. Le spectacle débute. Muni de petites pinces argentées, notre serveur à nœud papillon retire avec cérémonie la garniture de concombre d’un empilement de nouilles biáng biáng du Shaanxi, de 1,2 m de long, puis en soulève une pour exposer sa surface grenue nappée d’huile pimentée et de champignon, avant de la couper à l’aide de ciseaux à filigrane doré. Nous salivons tel un chien de Pavlov de la Chine septentrionale.
Glamour et service sont un clin d’œil au décorum des vieilles grilladeries de Miami ou de Hollywood, adapté au jet-set de Yorkville. Mais des indices de l’âme culinaire bien plus rustique du Mimi se cachent dans l’antichambre des toilettes, où une photo noir et blanc d’un vendeur de nourriture ambulant grisonnant, prise par le chef David Schwartz à Chengdu, est accrochée au-dessus d’un coffre laqué noir incrusté de nacre.

La magie du Mimi – de l’équipe du Sunnys Chinese (primé ici en 2021), qui a fait un tabac durant la pandémie – tient dans la manière de restituer l’esprit de ces humbles cuisiniers et de leurs spécialités régionales. Cela donne des plats raffinés, sans égal, qui respectent la tradition tout en frappant par leur nouveauté. Cuit dans un four en pierre avec huile de cumin, poivre du Sichuan et sauce soya sucrée, le chou a des allures de guimauves

42
TORONTO MIMICHINESE.COM
03 S
A Chinese banquet hall-style feast starring Hunan chili sea bass and crisp shrimp toasts served with hot mustard mayo.

Banquet chinois où brillent un bar au chili de Hunan et des toasts de croustillantes crevettes avec mayo à la moutarde piquante.
Black and white and red all over: A baijiu-based Jungle Panda cocktail; Mimi’s kitchen crew in front of the red-numbered facade.

Le noir et blanc et rouge domine : un cocktail Jungle Panda à base de baiju; la brigade du Mimi pose devant la façade à l’adresse rouge.

43

Before neon lights go on, executive chef David Schwartz (right) makes a pit stop at Kyu Shon in Toronto’s Chinatown. Avant qu’apparaissent nœuds papillon et néons, le chef David Schwartz (à droite) fait un arrêt au Kyu Shon, dans le quartier chinois de Toronto.

Four-foot-long belt noodles offer a journey to Shaanxi Province and back in at least 20 bites. Ces nouilles ceintures de plus d’un mètre sont une virée dans la province de Shaanxi en 20 bouchées.

yellowtail sashimi dish once reserved for Guangdong royalty rests in a bright green pool of ginger oil, the mix deepened by soybeans and fermented rice. The shower of diced cucumber and chayote on top is so fine you worry for the chefs’ fingers.
“Everything is so delicate and yet so full of flavour,” my perspicacious friend notes. That goes for desserts too, like the comforting Guangdong steamed cake known as Ma Lai Go, over which our server pours a sweet rice cream. It’s China’s winning answer to sticky toffee pudding. The perfect end to a dazzling evening of high-glam ambiance and humble regional cuisine might be a flight of earthy baijiu, the distilled grain alcohol adored by magnates and street food hawkers alike.
rôties. Le sashimi de sériole, jadis réservé à la noblesse du Guangdong, nage dans une huile de gingembre vert vif, avec des fèves de soya et du riz fermenté. Minuscules, les dés de concombre et de chayote sur le dessus font craindre pour les doigts du chef.
« Tout est si délicat et pourtant si goûteux », résume mon vis-à-vis, perspicace. Cela vaut aussi pour les des serts, tel ce réconfortant gâteau étuvé du Guangdong appelé ma lai go sur lequel notre serveur verse une crème de riz gluant, délicieuse version chinoise du pouding au caramel. La conclusion parfaite d’une soirée réussie oscillant entre raffinement et modeste cuisine régionale : une rasade de baijiu, eau-de-vie de céréale prisée des magnats comme des marchands ambulants.


45
TBut once installed in this cozy dining room decorated with playful abstract art, our stress subsides as a plate of dense, housemade Danish rye arrives from the open kitchen across from us. It’s accompanied by a cup of rich, comforting “compost broth” made of upcycled ingredients. A commitment to reducing food waste is threaded throughout the Perch experience: Asparagus peels add a vegetal note to both the gin and the shrub in the Garden Party cocktail. All food scraps are turned into nutrient-dense soil through bokashi fermentation, and even the washroom soap has
Perch 04

e festival italien perturbe la circulation et nous met en retard pour notre menu dégustation. Mais une fois installés dans cette coquette salle ornée d’œuvres abstraites ludiques, la tension retombe lorsqu’une assiette d’un consistant pain de seigle danois maison sort de la cuisine à vue devant nous. Il s’accom pagne d’une réconfortante tasse de « bouillon de compost » fait d’ingrédients revalorisés. La réduction des déchets alimentaires, c’est la marotte du Perch (les pelures d’asperge donnent une touche végétale au gin et au shrub de son cocktail Garden Party). Tous les restes de cuisine et de table sont ici transformés en un sol riche en nutri ments, grâce à la technique de fermentation Bokashi, et



46
OTTAWA PERCHOTTAWA.CA
L
Nature meets baker with flowering, minimal-waste creations like buñelo, made with sourdough discard. Nature, boulange et créations fleuries font échec au gaspillage dans ce buñelo fait de restes de levain.
a sustainable story to tell (it’s made of spent espresso grounds and cooking oil).
Of course, chef Justin Champagne-Lagarde’s talents (ex of Ottawa’s Bar Lupulus and Atelier, and C Restaurant and Hawksworth in Vancouver before that) shine the brightest on the plate. The showstopper of the night is a silky Japanese-style chawanmushi (savoury egg custard) adorned with shio-koji aged quail breast, mushrooms, a coffee-cherry infusion and black garlic confit. Paired with a cocktail of Los Arango reposado tequila, bitters and sweet vermouth, together they make a tone poem of earthy, sweet and umami notes. Then there is the Dijon-mustard-spiked macaron over which is piped a delicate scallop mousse, accented with smoked Vancouver Island salt and herbaceous garnishes. It’s as ethereal as the chawanmushi is earthy.
Outside, the Italian festival rages on. A riot of rainbowcoloured umbrellas passes by, and costumed acrobats manoeuvre on stilts. For all of its pageantry, it can’t touch the spectacle of ideas, textures and tastes we’re experiencing inside.
même le savon des toilettes, fait de marc d’espresso et de vieille huile de cuisson, est écoresponsable. Évidemment, la virtuosité du chef Justin ChampagneLagarde (ex de l’Atelier et du Bar Lupulus, à Ottawa, et du C Restaurant et du Hawksworth, à Vancouver) s’ex prime surtout dans l’assiette. Le clou de la soirée : un soyeux chawanmushi (crème aux œufs salée japonaise), avec poitrine de caille vieillie au shio-koji, champignons, infusion café-cerise et ail noir. Arrosée d’un cocktail de téquila Los Arango, de bitter et de vermouth doux, c’est une ode à la terre, à la douceur et à l’umami. Et puis il y a ce macaron à la moutarde de Dijon, coiffé à la poche à douille d’une délicate mousse de pétoncles assaisonnée de garnitures herbacées et de sel fumé de l’île de Vancouver. Le résultat : aussi aérien que le chawanmushi était terrien.
Dehors, le festival italien bat son plein, joyeux brouhaha de parapluies arc-en-ciel et d’acrobates en costume perchés sur des échasses. Ça a de la gueule ; mais ça ne fait pas le poids devant le spectacle d’idées, de textures et de saveurs auquel nous venons d’assister à l’intérieur.
Chef Justin ChampagneLagarde pours a dulse broth over a mussel dish with sea asparagus and truffles. Le chef Justin Champagne-Lagarde verse un bouillon de dulse sur une assiette de moules avec de salicorne et de truffes.
Perch is named, in part, for its open dining room, which perches guests in view of the kitchen.

Perch a été baptisé ainsi, entre autres, pour sa salle à manger ouverte qui perche les convives en vue de la cuisine.

47
Mô . t Tô




48 CALGARY MOTTOVIETNAMESE.COM
05
Go beyond banh mi with crab and pork tomato soup, crispy pho grilled cheese and ribeye carpaccio. Faites changement du banh mi avec cette soupe crabe et porc, ce grilled cheese croustillant et ce carpaccio de faux-filet.
Between the electric flavours and decor, owners Sarah Luong, Long Thai and their daughter Hannah make a dynamic trio. Entre les saveurs électrisantes et la déco, les proprios Sarah Luong, Long Thai et leur fille Hannah forment un énergique trio.


Think of this Crescent Heights spot as the more self-assured, prom-going, secondgeneration teenage offspring of crosstown parent Phô Dâu Bò. This is where you want to drop in at all hours to snack, gossip and listen to BTS and Nick Jonas tunes. A breezy, youthful attitude holds sway amid sheepskin throw-covered wicker chairs and tables made from upcycled wooden chopsticks, while the menu puts polished, creative hybrid dishes alongside pho soups and banh mi sandwiches.
The slap-in-the-face invigorating coconut iced coffee is a tall, columnar cloud of white coconut slushy that rises like a prairie snowdrift above a glass filled with sweet Vietnamese coffee. The genius, super crispy pho grilled cheese deconstructs the classic noodle soup by serving it alongside a shot of scallion-flecked pho broth for dipping, leaving Velveeta panting in the dust. Roasted bone marrow and mini toasts are the decadently rich and fatty opposite of a palate cleanser.
The refreshing follow-up, a magical rare rib-eye carpaccio, is like a play on steak tartare that connects Calgary and Hanoi. Bathed in a sweetly pungent, spicy lime vinaigrette, it’s loaded with fresh basil, bright red bird’s-eye chili and thinly sliced onion, then topped with a raw quail egg and showered with crispy deepfried shallots.
A sign in pink neon cursive reads, “This is what you came Pho.” To which, by the end of this crazy, rich meal, we want to reply, “Pho sure!” and high-five owners Sarah Luong and Long Thai.
Ce resto de Crescent Heights, c’est le rejeton de deuxième génération du Phô Dâu Bò, à l’autre bout de la ville ; celui qui a pris de l’assurance et qui est fin prêt pour son bal de finissants. C’est aussi l’endroit où prendre une bouchée, potiner et entendre du BTS ou du Nick Jonas à toute heure du jour. L’ambiance est jeune et décontractée dans un décor de chaises en osier habillées de peaux de mouton et de tables en baguettes de bois recyclées. Au menu se côtoient plats fusion créatifs et léchés, phôs et banh mis.
Le café glacé à la noix de coco (vivifiant) est un verre de café vietnamien sucré sur lequel une colonne nuageuse désordonnée de barbotine à la noix de coco s’est amoncelée façon congère des Prairies. Le pho grilled cheese (génialement croustillant) est une réinterprétation du classique sandwich au fromage (on le trempe dans un phô moucheté d’oignons verts et on oublie celui au Velveeta). Le gras de la moelle rôtie et des rôties miniatures n’ont rien d’un trou normand.


Ce qui suit est plus rafraîchissant : le carpaccio de faux-filet de bœuf saignant (magique) est une déclinaison du tartare qui relie Calgary à Hanoï. Baigné dans une vinaigrette à la lime doucement épicée, copieusement assaisonné de basilic, de piment oiseau rouge vif et de fines tranches d’oignon, il est garni d’un œuf de caille cru et d’une pluie croustillante d’échalotes frites.
Après avoir englouti ce repas riche et follement délicieux, rien ne nous retient de faire des propriétaires Sarah Luong et Long Thai nos nouveaux meilleurs amis pour la vie.
49
Heart’s Tavern and Bar 06

s we burble with delight over our plate of silky house-smoked salmon on baguette, dusted with freshly grated horseradish and goosed with pickled jalapeños, our bearded, Chuck Taylor-clad server lets us in on the secret behind the accompanying jet-black cultured butter that tastes of the sea. “We salt it to cut off fermentation, then add the squid ink.” That confirms what we’ve suspected from the moment we entered this retro roadside tavern in the heart of Grey County’s Beaver Valley: We’re not really in rural Ontario anymore.
Instead, we find ourselves in some mythical Alpine chalet, where the old wooden floors and beams glow in candlelight and large slabs of beef hang curing alongside


A Tandis que nous marmonnons notre joie devant notre assiette de soyeux saumon fumé maison sur baguette garni de raifort râpé et de jalape no mariné, notre serveur barbu et chaussé de Chuck Taylor nous révèle le secret de fabrication du beurre de culture couleur jais au goût marin qui l’accompagne. « On le sale pour freiner la fermentation, puis on ajoute l’encre de seiche. » Nos soupçons se confirment : cette taverne rétro de bord de route a beau être au cœur de la Beaver Valley du comté de Grey, nous avons bien quitté l’Ontario rural. L’endroit où nous nous trouvons a plutôt à voir avec un chalet suisse dont le vieux plancher et les poutres luisent à la lumière des bougies et où des pièces de bœuf pendent près de bocaux de noix et de cornichons marinés. Sur un

50
KIMBERLEY ON HEARTSGREYCOUNTY.CA
Fit for the country: Heart’s staff don trucker caps and Chucks. Contexte champêtre : le personnel du Heart's porte casquette et baskets.
jars of pickled walnuts and cornichons. On a nearby countertop cake stand, a freshly baked cheesecake preens. The honeyed lighting, the deep, stone-walled wine cellar fitted with one long wooden table and hung with red velvet curtains – this feels like a timeburnished mountain hideaway where generations of cooks have been tending the hearth.
In reality, it’s the latest creation from the team behind Union and Côte de Boeuf in Toronto, who have brought their love of “simple food, done well” to the countryside 150 kilometres north. Their vision of rural hospitality is warm, detailed and winning. What saves Heart’s from being almost too movie-set perfect is its food, which is good enough to make your “last meal on Earth” list. While you’re still alive and kicking, go for a slab of 60-day air-cured grilled steak, or maybe that demi-glace-wreathed roasted chicken (raised by a guy named Gus), plus a glass or two of lowintervention European wines (like the crazy grapefruit zing of a Sicilian fermented-on-lees 2021 Abir Zibibbo). Set your internal GPS back to North America on your way home, lest you lose your way in the dark.

comptoir, un gâteau au fromage tout juste sorti du four fait le beau dans son présentoir. L’éclairage aux reflets de miel, la cave à vin aux murs de pierre à la longue table en bois et aux rideaux de velours rouge, tout évoque un re fuge montagnard patiné par le temps, au foyer duquel des générations de cuisiniers se sont succédé.
En réalité, il s’agit de la dernière création de l’équipe des restos torontois Union et Côte de Bœuf, qui a trans posé son amour d’une cuisine simple et bien faite à la campagne, 150 km au nord. Sa vision de l’hospitalité rurale, très réussie, en est une de chaleur et de petits détails. Mais ce qui sauve le Heart’s du « trop beau pour être vrai », ce sont ses plats, assez délectables pour figurer à votre palmarès des lieux où prendre votre dernier repas. Puisque vous êtes toujours de ce monde, optez pour le steak grillé séché à l’air libre pendant 60 jours ou le poulet rôti demi-glace (élevé par un certain Gus) avec un verre (ou deux) d’un cru nature européen, comme ce zibibbo Abir 2021, un sicilien sur lie aux intenses notes de pamplemousse. Pour rentrer chez vous, réglez votre GPS interne sur Amérique du Nord, pour ne pas vous perdre dans le noir.
Dating back to the 1800s, the roadside tavern house was last home to the Village Inn. Datant des années 1800, la taverne en bord de route hébergeait autrefois le Village Inn.
From sweet to savoury, eat your heart out on sticky ginger cake, lobster green salad and burrata. De l’entrée au dessert, remplissez-vous la panse avec burrata, salade de homard et gâteau au gingembre collant.

Fonda Balam




52 TORONTO FONDABALAM.COM
07
Chefs Julio Guajardo and Kate Chomyshyn bid diners bienvenida; housemade corn totopos, hot for the dipping.

Les chefs Julio Guajardo et Kate Chomyshyn souhaitent bienvenidos aux clients; totopos maison prêts à la trempette.
Start with the scallop aguachile then try your hand at the loaded quesabirria con consome. Commencez par l’aguachile de pétoncles, puis plongez dans le généreux plat de quesabirria con consomé.


emerge Simpsons that bears amorous tongue-in-cheek slogans like “U stink, wish you were her.” Against a backdrop of retro glass-brick walls, pastel-glowing porthole lights and beaded bull skulls, a trio of women who work in web development advise us that we don’t need to order the three side salsas – two of them come with the quesabirria. Around the room, several mom-and-kid duos go to town on shrimp cocktails, while in a nearby corner, a man with a Fu Manchu moustache and round hornedrimmed glasses studies the menu.
But enough about the variegated cross-section of food-obsessed Toronto society we find in this white brick-clad Dundas West joint from a team that includes restaurant impresario Matty Matheson and husbandand-wife chef duo Julio Guajardo and Kate Chomyshyn (who also opened Grant van Gameren’s Quetzal in 2018). The real story here is its polished take on Mexican street food: so addictive you may need to go to taco rehab to kick the habit.
Those glass parfait bowls of coctel de camarón are the avocado-studded house take on shrimp cocktail, bathed in a spicy Clamato sauce. The star of the show is the aforementioned quesabirria con consome, two corn tortillas stuffed with five-hour braised beef chuck and brisket, cheese and aromatics, grilled until its edges are crispy, all of it to be dipped in consommé before eating. Scrolling Instagram while dining is not an option due to the neon-orange beef fat streaming down your wrists.
With a kitchen this crafty, we’re happy we ordered the tender tres leches sponge cake with strawberries and a vanilla and white chocolate crémeux. But the insatiable trio of web developers has already departed for the next stop on their food crawl, unaware of the treasures they have left untasted.
Les bras abondamment tatoués de notre serveur émergent d’un t-shirt de Saint-Valentin des Simpson au slogan dont l’humour se perd à la traduction. Sur fond de briques de verre rétro, de lampes hublots pastel et de crânes de taureau perlés, trois développeuses web nous informent qu’il n’est pas nécessaire de prendre les trois salsas d’accompagne ment (deux sont servies avec la quesabirria). Dans la salle, des duos mère-enfant se régalent de cocktails de crevettes et, dans un coin, un homme à la moustache Fu Manchu et aux lunettes rondes en écaille étudie le menu.
Assez parlé de l’échantillon bigarré des gourmands torontois qui fréquentent ce bistro aux briques blanches de Dundas West et dont l’équipe comprend le restaurateur en série Matty Matheson et les époux Kate Chomyshyn et Julio Guajardo (qui ont ouvert le Quetzal avec Grant van Gameren en 2018). Ce qui compte, c’est la préparation soignée de mets de cuisine de rue mexi caine si addictifs qu’il vous faudra peut-être suivre une cure de désintox.

Dans un bol en verre à pied, le coctel de camarones est un cocktail de crevettes coiffé d’avocat et baignant dans une sauce Clamato épicée. La fameuse quesabirria con consomé (deux tortillas de maïs farcies de macreuse et de poitrine de bœuf braisées pendant cinq heures, de fromage et d’aromates, grillées jusqu’à ce que les bords soient croustillants et qu’on trempe dans un consommé) vole ici la vedette. Ne consultez pas Instagram en man geant ; de la graisse de bœuf orange fluo pourrait bien ruisseler sur vos poignets.
Tant de talent en cuisine fait que nous sommes ravis d’avoir commandé le tendre gâteau aux trois laits avec fraises et crémeux vanille-chocolat blanc. Mais notre insatiable trio de développeuses web déjà remis en route, laissant derrière des trésors pas encore goûtés.
53
Major Tom

54 08 CALGARY
Pastry chef Jordan Hartl fires up dessert with the boozy “Old Fashioned” Baked Alaska. Le chef pâtissier Jordan Hartl flambe cette omelette norvégienne avec un alcoolisé Old Fashioned.
Meet the majors: Executive chef Garrett Martin and chef de cuisine Garrett Rotel take the steakhouse menu to new heights. Rencontrez les majors : les chefs Garrett Martin et Garrett Rotel, qui élèvent le grilladerie vers de nouveaux sommets.



Visiting Major Tom is like riding a wellappointed, solar-powered rocket ship to a distant galaxy for a good Alberta steak. Our space odyssey begins at Stephen Avenue Place in downtown Calgary where we’re directed to an express elevator that launches us up to the 40th floor.
The glittering 198-seat dining room soars above the land, showcasing the wide-open prairie below so expansively, it feels like you could walk the floor forever to take in the panoramic views. Or, you could settle into Frank Architecture’s vision of a late-1960s, dark wood-, leatherand bronze-accented luxury spaceship, for which the wickedly clever bon vivant Truman Capote was the inspiration. His spirit twin, a dandyish server, glides by in shorts and loafers – not to mention a blue cravat.
ller au Major Tom, c’est un peu comme monter à bord d’une fusée solaire dernier cri pour rejoindre une lointaine galaxie et manger un bon steak albertain. Notre odyssée de l’espace débute dans le Stephen Avenue Place, au centre-ville de Calgary, où l’ascenseur express nous propulse au 40e étage.
La salle à manger rutilante de 198 places surplombant la prairie embrasse le paysage ; le spectacle est si grandiose qu’on pourrait à tout jamais arpenter la pièce pour boire le panorama. On peut, sinon, digérer la vision de l’agence Frank Architecture : un vaisseau spatial luxueux de la fin des années 1960 aux accents bois foncé, cuir et bronze, dont Truman Capote, bon vivant à l’intelligence redoutable, est l’inspiration. Son jumeau spirituel, un serveur dandy en short, flâneurs et cravate bleue, se faufile entre les tables.
55
A
Nibble on Alberta snow peas in parmesan and crispy hen egg with pepperoni jam in a dining room with a view. Pois mange-tout albertains au parmesan à grignoter, œuf de poule craquant et confiture de pepperoni, vue sympa en prime.

The cocktails are so good you will forget your space fright: Major Tom “originals,” “covers” of classics and, for grown-up space cadets, hibiscus Jell-O shots made with a naturally fermented Hungarian red wine. We tuck into a fresh and lively golden beet salad dotted with smoked cheddar, horseradish and woodsy pine-nut vinaigrette, and then a savoury plate of English-cut prime rib from Alberta Prime. (No need to take your protein pills.) Major Tom’s head may be in outer space, but its careful sourcing is down to earth, calling on farms and ranches planted on provincial soil below.
The haunting scent of bergamot in the Earl Grey mousse of your London Fog Verrine dessert will linger on, further proof that Major Tom has really made the grade.

Les cocktails sont si bons qu’on oublie toute peur des hauteurs : « originaux » du Major Tom, « reprises » de classiques et, pour les cadets de l’espace (adultes), rasades de Jell-O à l’hibiscus à base de vin rouge hongrois à fer mentation naturelle. Nous nous régalons d’une fraîche salade de betteraves jaunes (cheddar fumé, raifort, vinaigrette aux pignons), puis d’une délicieuse côte de bœuf de coupe anglaise Alberta Prime (nul besoin de suppléments protéinés). Au Major Tom, on a peut-être la tête dans les nuages, mais l’approvisionnement, lui, est terre-à-terre, auprès de fermes et de ranchs triés sur le volet, dans le terroir provincial, 40 étages plus bas.
Impossible d’oublier le parfum envoûtant de la bergamote dans la mousse à l’earl grey de la verrine London Fog ; voilà une autre preuve que le Major Tom a gagné ses galons.

56
Japanese whiskey offers a twist on the Manhattan
Un whisky japonais donne un coup de jeune au manhattan
MAJOR TOM COCKTAIL OF THE YEAR COCKTAIL DE L’ANNÉE
Montenegro amaro and apricot liqueur stand in for vermouth and Luxardo cherry
Amaro Montenegro et liqueur d’abricot remplacent vermouth et cerise Luxardo
All the Way Up: Suntory Toki Japanese whisky, Montenegro amaro, apricot liqueur and pistachio.
L’All The Way Up : whisky japonais Toki de Suntory, amaro Montenegro, liqueur d’abricot, pistaches.

Fox & Monocle




58 NORTH SAANICH BC FOXANDMONOCLEBAKERY.COM
09
North Saanich’s best new restaurant, within a bike ride’s reach of Victoria, doubles as a café and pastry bar by day. Le meilleur nouveau resto de North Saanich à un saut de puce de Victoria en vélo, qui fait aussi café et pâtisseries, en journée.
By night, duck breast with blackberries and a chèvre and tomato garden salad delight. Au souper : poitrine de canard avec mûres et une exquise salade chèvre-tomates du jardin.


Something’s up in North Saanich’s sleepy Canoe Cove, and it’s not just the tide. Out of a plain box of a waterfront café – so unassuming that you have to circle around to the side of the building to find the washroom – chefs and IRL couple Ross Bowles and Tracie Zahavich have devised a menu inspired by modern European cuisine: elevated, comforting food that nods to tradition.
As unadorned as the room is, with its Shaker-style simplicity and antique cookware decor, there’s no hiding the kitchen’s fine dining pedigree: Bowles was sous chef under chef Rob Cassels at Victoria’s Saveur Restaurant and executive chef at the River Café in Calgary. He met Zahavich, a fellow Albertan, when she turned out to be his senior, as demi pastry cook, at Gordon Ramsay’s three-Michelin-starred resto in London.
That pedigree is apparent in his plump, sweet and super-fresh B.C. spot prawns reposing on a blanket of roasted red peppers dotted with crispy polenta croutons. One bite of the symphony of silkiness, briny umami and crunch and I know I’ll follow him anywhere. Ditto for her desserts, which range from precisionengineered building blocks of short crust, hazelnut praline and chocolate parfait bar to a comforting Eton mess. Elevated, but comforting, right? It’s the Fox & Monocle way: She’s his fox, and he, with his insatiable curiosity, is her monocle. Together, they’re ready to conquer the kitchen and beyond.
uelque chose monte dans la paisible anse Canoe de North Saanich, et ce n’est pas la marée. Dans un café de bord de mer sans cachet architectural (une simple boîte), si modeste qu’il faut en faire le tour à l’extérieur pour trouver les toilettes, les chefs et époux Ross Bowles et Tracie Zahavich signent un menu qui s’inspire de la cuisine européenne moderne : raffiné, réconfortant et respectueux de la tradition.
Le dépouillement style Shaker de sa salle (avec ustensiles de cuisine anciens comme décoration) ne reflète en rien le pedigree en cuisine : M. Bowles a été sous-chef de Rob Cassels au Saveur de Victoria et chef de cuisine au River Café de Calgary. Il a rencontré sa douce à Londres, quand celle-ci, compatriote albertaine, était demi-cheffe de partie pâtisserie, et donc sa supérieure, au trois étoiles Michelin de Gordon Ramsay.

Le pedigree de monsieur est évident dans son plat de crevettes tachées du cru, dodues, sucrées et super fraîches, sur lit de poivrons rouges rôtis et servies avec croûtons de polenta. Une seule bouchée de cette symphonie veloutée d’umami salin et de croquant donne envie de le suivre au bout du monde. Idem pour les desserts de madame, qui vont d’un ingénieux assemblage de pâte brisée, de praliné aux noisettes et d’une barre de parfait au chocolat au fouillis ravigotant d’un Eton mess. Raffiné et réconfortant. C’est la méthode Fox & Monocle : elle est la renarde et lui, avec sa curiosité inépuisable, le monocle. Ensemble, ils sont prêts à conquérir la gastronomie.

59
Chefs Tracie Zahavich and Ross Bowles. Les chefs Tracie Zahavich et Ross Bowles.
Q
Restaurant Alentours 10
ur bearded, apron-clad server’s food and wine descriptions are so detailed that after our first bite of a creamy, crunchy and tangy salad of cooked and fried yellow peas napped with a cucumber vinaigrette, dill and chives, we feel like we’re practically friends with the Rastafarian organic farmer who grew the cukes.
Chef Tim Moroney has embraced the sustainable, locavore ethos absorbed during his time at Blue Hill in New York and Relæ in Copenhagen, and the woodclad, meditative feel of his Quebec City neighbourhood place is a nod to those former homes – even down to the Relæ-style utensil drawer hidden in our tables. Only ingredients sourced from within 150 kilometres are considered fair game for Moroney’s kitchen (ethically produced salt, yeast, milk and cream are the exceptions). So he’s swapped in a yellow pea polenta for the emulsifying qualities of olive oil in the vinaigrette, and lacto-fermented those cucumbers to make them zing.




es descriptions du plat et du vin que fait notre serveur barbu en tablier sont si détaillées qu’après une bouchée de notre salade crémeuse, croquante et acidulée de pois jaunes cuits et frits nappés d’une vinaigrette concombre, aneth et ciboulette, nous avons l’impression de connaître le fermier bio rastafari qui a cultivé les cucurbitacées.
C’est en travaillant au Blue Hill de New York et au Relæ de Copenhague que Tim Moroney a adopté des principes de restauration durable et d’achat local. Le caractère méditatif de son resto de quartier tout de bois vêtu de Québec est un clin d’œil à ces établissements – jusqu’au tiroir à ustensiles de style Relæ des tables. Seuls des ingrédients provenant d’un rayon de 150 km entrent dans la cuisine du chef (sel, levure, lait et crème de production respon sable font exception). Il a donc troqué huile d’olive aux propriétés émulsifiantes pour une polenta de pois jaunes dans la vinaigrette, et soumis les concombres à la lactofermentation pour préserver leur vivacité.
60
QUEBEC CITY QUÉBEC RESTAURANTALENTOURS.COM O L
Ask host Alexandre Ruel where the festin is from and he’ll say Fromagerie Grondines run by Charles and Guylaine.

Demandez à l’hôte Alexandre Ruel d’où vient le festin, il vous répondra « de la Fromagerie Grondines de Charles et Guylaine ».

Around here, Frédérique Hamel, Tim Moroney, Emaelle Brault-Gingras and Ruel let little go to waste. Ici, Frédérique Hamel, Tim Moroney, Emaelle Brault-Gingras et M. Ruel ne gaspillent pas grand-chose.
This is no dour scolding for gourmands with big carbon footprints, but a joyful, meticulously prepared celebration and snapshot of what’s in season now on the fields and farms of the surroundings – or alentours A potato and celeriac dish, spiked with a fresh, dried and pickled jalapeño salsa and a caramelized corn cob broth-based beurre Nantais, unlocks new vegetable dimensions. Optional wine and cider pairings provide another alluring layer of Quebec terroir: A honey- and yellow flower-scented Saint-Pépin 2020 from Domaine Le Grand Saint-Charles with the salad course, and a buttery, quince-nosed Vignoble Camy Reserve chardonnay with the potato.
So no, this tour of the provincial alentours is not penance, but pure pleasure, where necessity is the mother of invention, and sustainable dining takes a thoughtful leap forward. Quebec City, and the food community outside its walls, are the better for it.

Il ne s’agit pas de culpabiliser les gourmands à forte empreinte carbone, mais de célébrer joyeusement et soigneusement les produits de saison des champs et des fermes des alentours. Un plat de pommes de terre et céleri-rave, avec fraîche salsa de jalapeno séché et mariné et beurre nantais au bouillon d’épis de maïs caramélisé, ouvre de nouvelles perspectives végétales. Les accords (facultatifs) de vins et cidres – un Saint-Pépin 2020 au nez de miel et de fleurs jaunes du domaine Le Grand Saint-Charles, avec la salade, et un chardonnay réserve au nez de coing et de beurre du Vignoble Camy, avec les pommes de terre – font aussi chanter le terroir québécois.
Cette tournée des alentours n’a rien d’une pénitence ; elle est pure partie de plaisir, où nécessité fait (délicieuse) loi et où la restauration durable fait un bond en avant réfléchi. La ville de Québec et ses fournisseurs extra-muros ne s’en portent que mieux.
61
The 2022 Longlist Les finalistes 2022
Discover the 30 spots that were in the running for the Canada’s Best New Restaurants Top 10 list. Découvrez les 30 adresses qui étaient en lice pour le palmarès Meilleurs nouveaux restos canadiens.
Bar Susu
209 EAST 6TH AVE. VANCOUVER, BC thisisbarsusu.com
Le Clan
44, RUE DES JARDINS QUÉBEC, QC restaurantleclan.com
Delara
2272 WEST 4TH AVE. VANCOUVER, BC delararestaurant.ca
Drift 1709 LOWER WATER ST., #102 HALIFAX, NS drifthalifax.com
Elephant 1879 POWELL ST. VANCOUVER, BC elephantinvancouver.com
Fonda Balam
802 DUNDAS ST. W TORONTO, ON fondabalam.com
Fox & Monocle
2300 CANOE COVE RD. NORTH SAANICH, BC foxandmonoclebakery.com
Fu’s Repair Shop
9902 109TH ST. NW EDMONTON, AB fusrepairshop.ca
Gia Vin & Grill
1025, RUE LENOIR MONTRÉAL, QC giagiagia.com
J’ai Feng
43, RUE BEAUBIEN E. MONTRÉAL, QC jaifengmtl.com
Jeju 120 4TH ST., #101 TOFINO, BC jejutofino.com
Hayloft Steak + Fish 639 CAMERON HEIGHTS DR. NW EDMONTON, AB robertspencerhosp.com/hayloft
Heart’s Tavern & Bar 235334 GREY COUNTY RD. 13 KIMBERLEY, ON heartsgreycounty.ca
Major Tom 700 2ND ST. SW, 40TH FLOOR CALGARY, AB majortombar.ca
Mastard
1879, RUE BÉLANGER MONTRÉAL, QC restaurantmastard.com
Mimi Chinese
265 DAVENPORT RD. TORONTO, ON mimichinese.com
Mokili
93, RUE DE CASTELNAU E. MONTRÉAL, QC mokili.ca
Mô . t Tô 1609 CENTRE ST. NW, #101 CALGARY, AB mottovietnamese.com
Namjim at Bannerman Brewing Co. 90 DUCKWORTH ST. ST. JOHN’S, NL bannermanbrewing.com
Nola
300 TACHE AVE., #101 WINNIPEG, MB nolawpg.com
Osteria Giulia 134 AVENUE RD. TORONTO, ON osteriagiulia.ca
Parcelles
21, CH. TAYLOR AUSTIN, QC parcellesaustin.com
Pei Pei Chei Ow
11051 97TH ST. NW, #102 EDMONTON, AB peipeicheiow.com
Perch
300 PRESTON ST., #1 OTTAWA, ON perchottawa.ca
Pichai
5985, RUE SAINT-HUBERT MONTRÉAL, QC pichai.biz


Pop Wine Bar 334 20TH ST. W SASKATOON, SK popwinebar.ca
Prime Seafood Palace 944 QUEEN ST. W TORONTO, ON primeseafoodpalace.ca
Restaurant 20 Victoria 20 VICTORIA ST. TORONTO, ON twentyvictoria
Restaurant Alentours

715, RUE SAINT-BERNARD QUÉBEC, QC restaurantalentours.com
Roy’s Korean Kitchen
2024 4TH ST. SW CALGARY, AB royskoreankitchen.com
62
PRESENTED BY PRÉSENTÉ PAR
Best Trailblazer Meilleur resto pionnier
Pei Pei Chei Ow
“Pei Pei Chei Ow” is the childhood nickname given to chef Scott Jonathan Iserhoff by his grandfather. It means “robin” in Omushkegowin (Swampy Cree). « Pei Pei Chei Ow » est le surnom que le grand-père du chef Scott Jonathan Iserhoff lui donnait. Ça signifie « merle d’Amérique » en omushkegowin (cri des marais).
ood as culture, history and community is what you will find at this takeout spot, housed in the Indigenous-owned Whiskeyjack Art House. A lemony sandwich of breaded deep-fried Spam (a nod to food rationed on reserves), parsley and horseradish, or another of eggplant, tomato jam, aioli kale, mint and pea shoots vibrate with the energy of the land, inspired by chef Scott Jonathan Iserhoff’s walks through wild-herb-scented forests of his childhood in northern Ontario.

His dream is to expand Pei Pei Chei Ow (pronounced “pe-pe-s-chew”) into a full-fledged restaurant where he can host various Indigenous chefs to pass on their knowledge to young people in the community. Just as he is most alive when cooking his own food, he hopes to inject that sense of identity through food to a new generation of Indigenous restaurateurs and chefs. “When I’m cooking,” he explains, “all my stories come back to me.”

a cuisine comme culture, l’histoire et le sentiment de communauté, voilà ce que propose ce comptoir de plats à emporter sis dans la ga lerie autochtone Whiskeyjack Art House. Un sandwich citronné au Spam pané frit (clin d’œil à la nourriture rationnée des réserves), avec persil et raifort, ou un autre d’aubergine, confiture de tomate, roquette sauvage, menthe et pousses de pois font écho à l’énergie de la terre, inspirés par les promenades du chef Scott Jonathan Iserhoff dans les forêts ontariennes de son enfance, qui embau ment les herbes sauvages.
Il rêve de transformer le Pei Pei Chei Ow (prononcez pipistchou) en resto à part entière où il pourrait recevoir des chefs autochtones qui transmettraient leur savoir aux jeunes de la communauté. Lui se sent vivant quand il cuisine ; il veut insuffler ce sentiment d’identité à une nouvelle génération de restaurateurs et de chefs autochtones. « Quand je cuisine, explique-t-il, toutes mes histoires me reviennent en mémoire.

63
»
F L PHOTOS: NOELLA STEINHAUER Read the full story at CanadasBestNewRestaurants.com. Lire l’article
complet
sur LesMeilleursNouveauxRestosCanadiens.com.
EDMONTON ALBERTA

(MOKILI).
PHOTOS: BEVERLEY TACO (BEVERLEY TACO SERVICE); JAI
Best New Pop-ups Meilleurs nouveaux restos éphémères
Our panel selects the dining experiences that made a mark last year, from spots that are still popping to those that have settled down. En mode éphémère ou permanent, ces tables ont été sélectionnées par nos experts pour les expé riences culinaires qu’elles ont offertes l’an dernier.
Best New Takeout Meilleurs nouveaux comptoirs pour emporter


From pandemic pivots to ma-and-pa shops, our panellists give a special nod to this much-loved restaurant format. Entre réinventions dues à pandémie et comptoirs familiaux, nos experts rendent un hommage particulier à cette formule de restauration si prisée.
Beverley Taco Service at/ à Sourwood Cider HALIFAX, NS beverleytacoservice
Black Cat Pizzeria at/ à Terre Restaurant ST. JOHN’S, NL blackcatpizzanl
Clos de la Oyster Barre at/ à Teatro Restaurant CALGARY, AB closdelaoysterbarre
Down Home with Sumac & Salt MARKDALE, ON sumacandsalt.com
HOB Fine Foods LANGFORD, BC hobfinefoods.ca
Naagan
by/ par Zach Keeshig OWEN SOUND, ON naagan.squarespace.com
Namjim at/ à Bannerman Brewing Co. ST. JOHN’S, NL namjim.nl
Odd Duck Wine and Provisions KITCHENER, ON oddduck.squarespace.com
The Soy Luck Club TORONTO, ON thesoyluckclub
Two Hands Dining Room at/ à One Sixteen WINNIPEG, MB onesixteenwpg.com
Bicycle Pizza
BRENTWOOD BAY, BC eatbicyclepizza.com
Gladys Caribbean Kitchen
WINNIPEG, MB gladyscaribbeankitchen.com
J’ai Feng MONTRÉAL, QC jaifengmtl.com
Mokili MONTRÉAL, QC mokili.ca
Ori Foods
DARTMOUTH, NS orifoodsco.com
Oroshi Fish Co. TORONTO, ON oroshifishco.com
Pei Pei Chei Ow EDMONTON, AB peipeicheiow.com
Pure Street Food CALGARY, AB purestreetfood
RPM Bakehouse JORDAN VILLAGE, ON rpmbakehouse.com
Sundog Trading Post YELLOWKNIFE, NT sundogtradingpost.ca
Read the full stories at CanadasBestNewRestaurants.com. Lire les articles complets sur LesMeilleursNouveauxRestosCanadiens.com.
KRISHNASWAMY
65
Learn
Take
Still Hungry?




Meet
Thank You to Our Sponsors Merci




Past
The
66
PHOTOS (CLOCKWISE FROM TOP LEFT): VIRGINIE GOSSELIN (TROPIKAL); SUPPLIED BY/FOURNIE PAR EDEN HAGOS; NAMJIM (NAMJIM); SANDY NICHOLSON (POMPETTE).
CanadasBestNewRestaurants.com LesMeilleursNouveauxRestosCanadiens.com Find many more food and drink stories at Et bien d’autres articles sur la gastronomie à
a bite out of our online stories. Dévorez nos articles en ligne.
à nos commanditaires
Encore faim ?
How We Find Canada’s Best New Restaurants Voyez comment on déniche les Meilleurs nouveaux restos canadiens
Top 6 Restaurant Trends Spotted on the Road This Year Les 6 grandes tendances restos observées cette année
the Panel of Experts Who Shaped This Year’s Longlist Découvrez les experts qui ont établi liste des finalistes cette année
Winners Dish on What It Takes to Open a Restaurant D’ex–lauréats discutent de ce qu’il faut pour ouvrir un restaurant



UNE COLLECTION D’EXTRAORDINAIRES WHERE AMAZING COMES TOGETHER ADVERTISEMENT

ADVERTISEMENT CURIOUS ABOUT CURAÇAO? CURIEUX À PROPOS DE CURAÇAO? 2
Get ready to discover the rich history and culture of Willemstad from the luxury of the newly opened Sandals® Royal Curaçao Resort. Here, you’ll be just as close to the city’s charming Dutch architecture as you are to the Caribbean’s natural beauty and warm waters. Come visit, and experience true ro mance in Curaçao.
Tenez-vous prêts à découvrir la riche culture et le passé remarquable de Willemstad depuis le luxueux et tout nouveau Sandals MD Royal Curaçao Resort. Ici, vous serez tout aussi près de la char mante architecture urbaine hollandaise que de la beauté naturelle et des eaux tropicales des Caraïbes. Rendez-leur visite et faites l’expérience d’une véritable histoire d’amour à Curaçao.

ADVERTISEMENT
vacancesaircanada.com3

ADVERTISEMENT
STAY SOMEWHERE SPECTACULAR
UN SÉJOUR SIMPLEMENT SPECTACULAIRE
Welcome to the newest oasis of luxury under the Sandals umbrella, where every aspect of the environ ment has been tailored to ensure the most romantic of getaways. Sun on the sand with your sweetheart while you stay at an Awa Seaside Bungalow, each one equipped with a private pool, personal butler and pic ture-perfect view of the Spanish Water or book a Kurason Island Suite overlooking an exclusive heart-shaped pool and private garden. With weather this welcoming, there’s no wrong choice for where you choose to lay your head.
After a day on the beach, relax with a drink at the swimup bar in the mesmerizing two-level Dos Awa infinity pool, the first of its kind at any Sandals resort, or explore the lush landscape on a Dutch bike. To end your day of fun and relaxation, sit back and enjoy an exclusive view of the stunning Caribbean sunset from the resort’s west ward shores.
Bienvenue à la toute nouvelle oasis luxueuse, signée Sandals. Chaque élément de son environnement a été conçu de manière à garantir une escapade amoureuse roman tique. Prenez un bain de soleil aux côtés de votre douce moitié puis un moment de relaxation dans votre bungalow balnéaire Awa, pourvu d’une piscine privée, d’un service de majordome personnalisé et d’une vue magnifique sur les eaux espagnoles. Ou alors, réservez une suite Kurason Island orientée face à une baignoire en forme de cœur et un jardin intime. Ici, la température est si clémente que vous vous sentirez bien, peu importe lequel des havres de paix vous choisirez.

Après une journée à vous prélasser sur la plage, relaxez au bar de l’envoûtante piscine à débordement à deux niveaux Dos Awa, la première en son genre à travers tous les complexes hôteliers Sandals. Ou bien, roulez à bicyclette typiquement hollandaise pour contempler le paysage luxuriant. Pour conclure votre journée de plaisir et de détente, asseyez-vous confortablement et profitez de la vue exclusive qu’offre la rive ouest de l’hôtel sur le superbe coucher de soleil des Caraïbes.

ADVERTISEMENT vacancesaircanada.com5
A FOODIE’S PARADISE
LE PARADIS DES GOURMANDS
There’s no better way to savour the world than with Sandals’ world-class vacation dining experience, where everything’s included, all the time. For quick delectable meals by the sea, try one of the three new food trucks, each available for lunch and dinner. If you’re interested in getting to know local tastes, Toteki offers Curaçaoan favourites, like beef kroketten. Try La Palma to sample classic Spanish dishes and tapas filled with fresh, sustainable seafood. Kishi serves up mouth-watering Asian-inspired baos, bowls, and curries for you to fuel your day with.
For more traditional dining experiences, Sandals offers eight restaurants with seven new concepts to delight your taste buds with. Start your morning off right with a stroop wafel and wash it down with a cup of Blue Mountain, the world’s finest coffee, at the Dutch Kanaal Café. Thanks to the new “Island Inclusive” off-site dining program, select guests can venture into the heart of Willemstad and ex perience a true taste of Curaçao’s cuisine and culture with a US$250 Dine Out Credit available at a carefully-curated collection of local restaurants.

L’expérience culinaire de calibre international que propose Sandals est le meilleur moyen de savourer le monde. Tout y est compris, et ce, à tout moment. Dégustez sur le bord de la mer des repas délectables de l’un des trois nouveaux camions-restaurants. Si vous désirez essayer de nouveaux produits locaux, Toteki offre des mets typiquement curaciens tels que le bœuf kroketten. Laissez-vous tenter par la cuisine espagnole classique servie chez La Palma ou goûtez à leurs tapas de fruits de mer frais et pêchés de manière durable. De son côté, Kishi suggère des délices sans pareil. Reprenez des forces à l’aide de leurs délicieux baos, bols et caris d’inspiration asiatique.
Délectez-vous d’encore plus d’aventures culinaires tradi tionnelles, car Sandals offre à vos papilles gustatives huit restaurants à sept concepts inédits. Débutez votre journée avec une stroopwafel et une tasse de café Blue Mountain, le meilleur au monde, du Dutch Kanaal Café. Au moyen d’un crédit de restauration de 250 $ US, les clients sélectionnés du nouveau programme gastronomique hors site « Island Inclusive » peuvent expérimenter la culture culinaire cura cienne, en plein cœur de Willemstad, dans des restaurants locaux minutieusement choisis.

ADVERTISEMENT 6 vacancesaircanada.com

ADVERTISEMENT

ADVERTISEMENT
LOVE IS ALL YOU NEED À DEUX, C’EST MIEUX
Planning a destination wedding? We’ve got you covered. Celebrate your love in Curaçao, the island of sweetness and spice. Sandals offers seven unique ceremony loca tions, ranging from the sun-kissed sands of Sunchi Beach, to the gorgeously landscaped flowers of the Welcome Garden, and the peaceful serenity of the Oceanview Wedding Pavilion.

Newlyweds are just as welcome! The best way to start any marriage is with a fantastic honeymoon. As a first for any Sandals Resort, guests in the Kurason Island Suites, or Awa Seaside Bungalows get access to an exclusive MINI Cooper, as well as a guided map, to see the sights of the island at their own pace. Why not take a drive down to Shete Boka National Park and walk the transcendental coast, or visit the Curaçao Liqueur Distillery for a tour and free samples of the good stuff.
Vous planifiez une noce sous les tropiques? Ne cher chez plus. Célébrez votre amour à Curaçao, terre de douceurs et d’épices. Sandals offre sept lieux de céré monies uniques, de la plage de sable éclatant Sunchi aux sentiers floraux magnifiquement aménagés du Welcome Garden, en passant par la sérénité apaisante du pavillon de mariage avec vue sur la mer.

Les nouveaux mariés sont aussi les bienvenus! Célébrez votre nouvelle vie à deux avec une lune de miel mémorable.
Les clients des suites Kurason Island ou des Bungalows balnéaires Awa auront à leur disposition une MINI Cooper et un guide routier pour voir tous les coins de l’île à leur rythme. Pourquoi ne pas conduire jusqu’au parc national Shete Boka et vous promener le long de la côte transcendante? Ou alors, vous pourriez assister à une visite privée de la distillerie Curaçao Liqueur Distillery et sirotez de l’eau-de-vie.
ADVERTISEMENT vacancesaircanada.com9
TOPEXCURSIONS
The landscape of Curaçao is renowned for its dualities, with the rugged northern coast peppered with inlets for turtles to lay eggs in, and the contemplative peace of Willemstad’s southern shoals. Luckily, there are plenty of local guides and excursions available for you to make the most of this island of sweetness and light.
Le paysage de Curaçao est réputé pour ses dualités, avec la côte nord accidentée parsemée de criques où les tortues peuvent pondre leurs œufs, et la paix contemplative des bancs du sud de Willemstad. Heureusement, de nombreux guides locaux et excursions sont à votre disposition pour vous permettre de profiter au maximum de cette île de douceur et de lumière.

ADVERTISEMENT
RACE YOU TO THE BEACH
For some high-octane excitement, hop on a high-performance ATV for an action-packed ride along the island’s west coast. Start your adventure out of the city by driving over the Queen Juliana Bridge, one of the highest van tage points in the island at 56.4 metres above sea level. Bask in the incredible panoramic views of Willemstad’s har bourfront, while ships pass beneath, then make stops at some of the most beautiful beaches on the island, like Kleine Knip or Playa Jeremi. Along the way, enjoy viewing the charming windmill-dotted landscape between flamboyances of flamingos.

1, 2, 3 PLAGE
Pour une montée d’adrénaline, roulez en bordure du littoral ouest de l’île à bord d’un véhicule tout-terrain. Amorcez votre périple hors de la ville en traversant le Queen Juliana Bridge, l’un des points de vue les plus hauts de l’île avec ses 56,4 mètres au-des sus du niveau de la mer. Plongez votre regard dans les vues panoramiques incroyables du port de Willemstad alors que des navires sillonnent les eaux. Prenez une pause sur les plages Kleine Knip et Playa Jeremi, les plus belles de Curaçao. En cours de route, contemplez le charmant pay sage parsemé de moulins à vent et de colonies de flamants roses.
FEEL THE WIND IN WILLEMSTAD
Tour the charming capital of Willemstad, a UNESCO World Heritage Site, the Dutch way with e-bikes to get a sense of the city’s eclectic architecture, without breaking the carbon bank. Head to the floating Queen Emma Bridge for an incredible view of the city’s colourful skyline, or visit the Maritime Museum of Curaçao to learn about the rich history of this 500-year old settlement. Afterwards, zoom through the iconic Punda and Otrabanda neighbourhoods before ending the day with a meal on the Handelskade waterfront.


RESPIREZ LA BRISE DE WILLEMSTAD
Montez sur une bicyclette électrique et faites le tour de la charmante capitale de Willemstad, site du pat rimoine mondial de l’UNESCO, pour admirer son architecture éclectique sans laisser d’empreinte écologique. Empruntez la route menant au Queen Emma Bridge et contemplez la vue sur l’horizon flamboyant de la ville. Visitez le Maritime Museum of Curaçao pour en apprendre sur cette colonie de 500 ans et sur sa riche histoire. Ensuite, filez vers les quartiers emblématiques de Punda et d’Otrabanda avant de conclure la journée avec un souper sur le front de mer d’Handelskade.
ISLANDER’S ESCAPE
If your first love is the sea, we have an adventure for you. Embark on a super yacht and sail to the small island of Klein Curaçao, just off the coast of the mainland. Although the island is cur rently uninhabited, it was once home to a rich mining industry, and remnants of its past life still sit undisturbed, such as the lighthouse and the shipwrecks of several boats along the shore. However, the real draw of Klein Curaçao is its incredible network of underwater caves and reefs, which you can go on an underwater tour of, before retiring to private shacks on the beach for an authentic island experience.

ESCAPADE INSULAIRE
Si la mer vous appelle, cette aventure est pour vous. Embarquez sur un su per-yacht et voguez jusqu’à la petite île de Klein Curaçao, située non loin du continent. Bien qu’elle soit actu ellement inhabitée, cette île a jadis fait partie d’une industrie minière fructueuse. Tout le long du rivage repo sent des vestiges du passé : un phare et des épaves de navires. En revanche, c’est l’incroyable réseau de caves et de coraux sous-marins qui capte réel lement l’attention vers Klein Curaçao. Assistez à une visite guidée des fonds marins avant de faire une pause sous une hutte de plage pour vivre une ex périence insulaire authentique.
ADVERTISEMENT vacancesaircanada.com11
par
pour
on new bookings of vacation packages at Sandals® Royal Curaçao made between November 1, 2022 and November 30, 2022, for travel between November 1, 2022 and April 30, 2023. Members can earn a maximum of 10,000 bonus Aeroplan points per person. The 20,000 bonus Aeroplan points offer is based on 2 Aeroplan Members sharing a Butler category accommodation. Members' Aeroplan number must be entered at time of booking. To qualify

the
the
number. Any booking made prior to the start of the Offer period that is subsequently changed to include travel
members must register for this offer at https://vacations.aircanada.com/en/aeroplan-register.
For terms and conditions of the Aeroplan program, visit aircanada.com/aeroplan-termsandconditions.
Flights operated by Air Canada or Air Canada Rouge. For applicable terms and conditions, visit www.aircanadavacations.
registration # R50013536 / W50013537. ■ Sandals® is a registered trademark. Unique Vacations, Inc. is an affiliate of Unique Travel Corp., the worldwide representative of Sandals Resorts. Aeroplan® and the Aeroplan logo are registered trademarks of Aeroplan Inc. Air Canada Vacations® is a registered trademark of Air Canada, used under license by Touram Limited Partnership. 1440 Ste Catherine St West, Suite 600, Montreal, QC, H3G 1R8. 5925 Airport Road, Suite 700, Mississauga, ON, L4V 1W1. I L’offre s’applique seulement aux nouvelles réservations de forfaits vacances au complexe Sandals MD Royal Curaçao effectuées entre le 1er novembre 2022 et le 30 novembre 2022, pour des voyages ayant lieu entre le 1er novembre 2022 et le 30 avril 2023. Les membres peuvent accumuler un maximum de 10 000 points-bonis Aéroplan par personne. L’offre des 20 000 points-bonis Aéroplan est établie selon deux (2) membres Aéroplan partageant une chambre de catégorie Butler. Le numéro Aéroplan des membres doit être entré au moment de la réservation. Afin de se qualifier comme nouvelle réservation, cette dernière doit être créée pour la première fois, avec un nouveau numéro de référence, au cours de la période promotionnelle. Toute réservation précédant le début de l’offre ou par la suite modifiée pour inclure des dates de voyage dans la période de voyage admissible ne sera pas considérée comme admissible à cette offre. Pour obtenir leurs points-bonis Aéroplan, les membres doivent s’inscrire à l’offre au https://vacations. aircanada.com/fr/aeroplan-inscrivez-vous. Aucun point ne sera remis en cas d’annulation de la réservation. Les points-bonis Aéroplan seront accordés une fois le voyage effectué. Pour connaître les conditions générales du programme Aéroplan, visitez aircanada.com/aeroplan-conditionsgenerales. Sous réserve de disponibilité au moment de la réservation. Les conditions générales peuvent être modifiées sans préavis. Vols exploités par Air Canada ou Air Canada Rouge. Pour les conditions générales applicables, visitez le www.vacancesaircanada.com. Titulaire d’un permis du Québec n o 702566. N o d’enregistrement TICO R50013536 / W50013537. ■ Sandals MD est une marque déposée. Uniques Vacations inc. est une entreprise
Holder of Quebec permit #702566.
de Unique Vacations Corp., le
mondial de Sandals Resorts. Aéroplan MD et le logo Aéroplan sont des marques déposées d'Aéroplan inc. Vacances Air Canada MD est une marque déposée d’Air Canada, utilisée sous licence par la société en commandite Touram, 1440, rue Sainte-Catherine Ouest, bureau 600, Montréal, QC H3G 1R8. 5925, Airport Road, Suite 700, Mississauga, ON L4V 1W1.
Applicable
as new,
booking must have been created for the first time during the eligible Offer period, with a new reference
dates within the qualifying travel period will not be considered a new booking that is eligible for the Offer. To obtain
bonus points,
No points will be awarded if the booking is cancelled. Bonus Aeroplan points will be awarded once travel has been completed.
Subject to availability at time of booking. Terms and conditions are subject to change without prior notice.
com.
TICO
affiliée
représentant
aircanadavacations.com BOOK YOUR DREAM VACATION BY NOVEMBER 30 FOR TRAVEL THROUGH APRIL 30, 2023 AND PER COUPLE 20,000 BONUS POINTS EARN UP TO 2,500 BONUS POINTS per guest for non-club room categories 5,000 BONUS POINTS per guest for Concierge room categories 10,000 BONUS POINTS per guest for Butler room categories vacancesaircanada.com D’ICI LE 30 NOVEMBRE, RÉSERVEZ UN VOYAGE AYANT LIEU AVANT LE 30 AVRIL 2023 ET ACCUMULEZ JUSQU'À PAR COUPLE 20 000 POINTS- BONIS 2 500 POINTS-BONIS par client pour les catégories de chambres autres que Club 5 000 POINTS-BONIS par client pour les catégories de chambres Concierge 10 000 POINTS-BONIS
client
les catégories de chambres Butler ADVERTISEMENT
CHEF ANTONIO PARK


A natural alternative to sugar Une alternative naturelle au sucre Made 100% in Canada | Fabriquée 100% au Canada WWW.CHEF-PARK.COM
Food Worth Flying for Across Canada Partout au Canada, des plats qui valent le déplacement
We asked Canada’s Best New Restaurants panellists to share the crave-worthy menu items they can’t forget, from starters to sweet treats. Nous avons demandé aux panélistes des Meilleurs nouveaux restos canadiens de nous faire part des plats les plus mémorables qui les ont fait saliver, des entrées aux desserts.

PAN DE JAMÓN
Noctua Bakery TORONTO, ON
SWEETGRASS AND WILD BLUEBERRY ICE CREAM
CRÈME GLACÉE AUX FOIN D’ODEUR ET BLEUETS SAUVAGES

Feast Café Bistro WINNIPEG, MB
Feast Café Bistro in Winnipeg has a menu inspired by traditional Indigenous foods and ingredients. “You need to try the sweetgrass ice cream. Smooth, creamy, subtle, floral and truly Canadian.” Le Feast Café Bistro de Winnipeg propose un menu inspiré d’aliments et d’ingrédients traditionnels autochtones. « Vous devez goûter la crème glacée au foin d’odeur. Douce, crémeuse, subtile, florale et vraiment canadienne. »
– Roger Mooking
Noctua Bakery started as a pop-up offering fresh pastries and breads that sold out every week. Now, they’ve got a permanent space in the Junction. “Daniel Sáez’s forearm-sized pan de jamón (a holiday-season special) is a gorgeous homage to the chef’s roots – feathery brioche dough wrapped around smoked bacon, Black Forest ham, boozy macerated raisins and Arbequina olives, accented with a touch of panela sugar.” À ses débuts, Noctua Bakery a occupé une série de restaurants éphémères où pâtisseries et pains frais s’écoulaient chaque semaine. Elle a maintenant son propre espace permanent du quartier Junction. « Le pan de jamón de Daniel Sáez, de la taille d’un avant-bras (un spécial des fêtes de fin d’année), est un magnifique hommage aux racines du chef – une pâte briochée légère enveloppant bacon, jambon Forêt-Noire, raisins macérés à l’alcool et olives Arbequina, le tout agrémenté d’une touche de sucre panela. »
– Tara O’Brady
SOURDOUGH FLATBREAD PAIN PLAT AU LEVAIN MULTIGRAINS GRILLÉ Delara VANCOUVER, BC
The sourdough flatbread at Delara, a modern Persian restaurant in Kitsilano, is made fresh in-house and served with seasonal dips. “Bread is such an important component of Persian culture. You can feel the love being passed from generation to generation.” Le pain plat au levain du Delara, un restaurant persan moderne de Kitsilano, est fraîchement préparé sur place et servi avec des trempettes de saison. « Le pain est une composante tellement importante de la culture persane. On peut sentir l’amour qui se transmet de génération en génération. »
– Aman Dosanj

68
PRESENTS PRÉSENTE AIR CANADA ENROUTE × AMERICAN EXPRESS ILLUSTRATIONS: SALINI PERERA
MOQUECA SOUP
SOUPE MOQUECA
Sundog Trading Post
YELLOWKNIFE, NT
This community hub and event space doubles as an ice cream parlour, coffee shop and casual restaurant. “Sundog Trading Post makes their own ice cream and delicious waffle cones. They also make delicious paninis and salads, and my all-time favourite, the moqueca soup: regional fish, coconut tomato broth, red peppers, chilies and cilantro-lime sauce.”
Ce centre communautaire et espace événementiel fait également office de glacier, café et restaurant décontracté. « Le Sundog Trading Post fabrique sa crème glacée et ses délicieux cornets gaufrés.
On y sert de savoureux paninis et salades, ainsi que ma préférée en carrière, la soupe moqueca : poisson de la région, bouillon de tomate à la noix de coco, poivrons rouges, piments et sauce coriandre-citron vert. »
Sousanh Chanthalangsy
APPLE FRITTER BEIGNET DE POMME
Halo Donuts
MONCTON, NB
Halo has made a name for itself thanks to its fresh-made doughnuts with bold icing colours and unique toppers (the Caramel Apple features a green glaze with flecks of toffee, while Cotton Candy is a tie-dye swirl of blues and pinks). “It’s very trendy in Moncton – people travel from everywhere to try their doughnuts. My favourite is the apple fritter.” Halo s’est fait un nom grâce à ses beignets frais au glaçage de couleurs vives et aux garnitures uniques (le Pomme caramel est couvert d’un nappage vert avec des éclats de caramel, tandis que le Barbe à papa est un mélange de bleu et de rose). « C’est très tendance à Moncton, les gens viennent de partout pour goûter ces créations. Mon préféré, c’est le beignet de pomme. »
Rahil Rathod
GREEN PEA SOUP

SOUPE DE POIS VERTS

Restaurant de l’Auberge Saint-Mathieu du lac SAINT-MATHIEU-DU-PARC, QC
In the tiny kitchen of this family-run inn, chef Samy Benabed creates an array of seasonal dishes inspired by Quebec terroir. If you’re lucky enough to see it on the menu, order “the cold green pea soup, garnished with charred peas, lemon basil and marjoram leaves, chive flowers, and a sprinkling of pea pod ashes.” Dans la minuscule cuisine de cette auberge familiale, le chef Samy Benabed crée un éventail de plats de saison inspirés du terroir québécois. Si vous avez la chance de la voir au menu, commandez « la soupe froide de pois verts, garnie de pois verts brûlés, de basilic citron, de marjolaine et de fleurs de ciboulette, le tout saupoudré de cendres de cosses de pois verts. »
Catherine Lefebvre
PLAIN JANE DIM SUM DIM SUM PLAIN JANE
Fu’s Repair Shop EDMONTON, AB
Fu’s Repair Shop may be known for its cool cocktails, but its all-day dim sum dishes like the buttery Plain Jane, topped in sesame and crispy fried shallots, are equally top-notch. “This dish is a flavour bomb. It’s so good, you’ll want to order seconds.” Fu’s Repair Shop est connu pour ses cocktails inventifs, mais les dim sums de toute la journée, comme le Plain Jane au beurre, garni de sésame et d’échalotes frites croustillantes, sont tout aussi excellents. « Celui-ci est une bombe de saveurs. C’est si bon que vous ne saurez vous satisfaire d’une portion. »
Shane Chartrand
KOREAN STEAMED BUNS
BRIOCHES CORÉENNES À LA VAPEURS
Dojo Ramen REGINA, SK
Co-owner Christopher Cho serves up his top childhood comfort foods at Dojo Ramen, a new Regina restaurant for Korean street food and Japanese ramen. “The pork-belly steamed buns are my favourite –soft and fluffy, filled with succulent, flavourful meat (or soy-glazed mushrooms) and crisp lettuce or family-recipe kimchi. My mouth waters just thinking about them.” Le copropriétaire Christopher Cho met au menu du Dojo Ramen, nouveau restaurant de cuisine de rue coréenne et de ramen japonais à Regina, certains des plats réconfortants de son enfance. « La brioche vapeur au flanc de porc a été ma préférée –des brioches souples et moelleuses farcies de viande savoureuse (ou de champignons glacés au soja) et de laitue croquante ou de kimchi selon une recette familiale. Je salive rien que d’y penser. » Allan Pulga
CHICKEN LIVER MOUSSE MOUSSE AU FOIE DE VOLAILLE Paname MONTRÉAL, QC
Seasonal Quebec ingredients take centre stage at this classic French bistro. Don’t miss Paname’s “velvety chicken liver mousse, topped with a crisp onion, potato and chicken-skin crumble and dollop of plum compote, served with a stack of lightly toasted brioche.” Les ingrédients québécois de saison sont la vedette dans ce bistro français classique.
Ne manquez pas « la mousse au foie de volaille veloutée, garnie d’un crumble croquant oignon, pomme de terre et peau de poulet, avec une cuillerée de compote de prune, le tout accompagné d’une pile de tranches de brioche légèrement grillées. »
Laura Osborne

69
ELEVATE YOUR TRAVEL AND DINING EXPERIENCES AS AN AMERICAN EXPRESS CARDMEMBER ÉLEVEZ VOS EXPÉRIENCES DE VOYAGE ET DE GASTRONOMIE EN TANT QUE TITULAIRE DE CARTE AMERICAN EXPRESS AMEX.CA/WHYAMEX
AIR CANADA ENROUTE × AMERICAN EXPRESS
Spirited Away
du malt

PHOTOS BY D’ ÉRIVER HIJANO WORDS BY TEXTE DE RENÉE MORRISON
L’âme
On the rugged coast of Scotland’s West Highlands, Nc’nean Distillery blends traditional whisky-making techniques with eco-innovation.
Sur le littoral découpé des Highlands de l’Ouest écossais, la Nc’nean Distillery marie production de scotch traditionnelle et éco-innovation.

Annabel Thomas isn’t afraid of change. After a life-altering sip on a trip to Islay, she swapped London office for Scottish cellar, setting up an organic distillery at her family’s remote farm in Drimnin, on the Morvern peninsula of the West Highlands. Her goal: to become a net-zero carbon emissions spirits producer. “I felt there wasn’t enough focus on sustainability in the industry.” Annabel Thomas ne craint pas le changement. Éblouie par un nectar siroté lors d’un séjour sur l’île d’Islay, elle a troqué son bureau londonien pour une cave écossaise et fondé une distillerie bio sur la ferme familiale de Drimnin, sur la péninsule du Morvern, dans l’ouest des Highlands. Son but : devenir une productrice de spiritueux carboneutre. « Je trouvais que l’industrie ne mettait pas assez l’accent sur la production durable. »
OPENING PAGES EN OUVERTURE
Every autumn, Nc’nean releases a special edition whisky blended by a staff member – “Quiet Rebels: Annabel,” inspired by Thomas, kicked off the series last year; In Fionnphort, Isle of Mull, visitors sit on the rocky coast eating fish ’n’ chips. Chaque automne, Nc’nean produit un scotch cuvée spéciale, assemblé par un membre de l’équipe, Quiet Rebels: Annabel, inspiré par Mme Thomas, lançant la série l’an dernier ; à Fionnphort, sur l’île de Mull, on déguste des fish’n’chips sur la côte.

72
Only four years after beginning production in 2017, Nc’nean made history as the first distillery in the United Kingdom to reach net-zero, a milestone achieved nearly 20 years ahead of the Scottish industry target of 2040 thanks to environmentally conscious practices, such as renewable timber energy, a rainwater cooling pond and 100 percent recycled glass bottles. “I’m incredibly proud of our small team, who have put their hearts and souls into overcoming the barriers to creating a delicious whisky with the smallest possible footprint,” says Thomas. Quatre ans seulement après le début de la production, en 2017, Nc’nean devenait la première distillerie britannique à atteindre la carboneutralité, 20 ans avant la cible de 2040 de l’industrie écossaise, avec des pratiques respectueuses de l’environnement : énergie renouvelable au bois, bassin de refroidissement à l’eau de pluie, bouteilles en verre 100 % recyclé. « Je suis très fière de notre petite équipe, qui s’est entièrement investie pour surmonter les obstacles à la création d’un délicieux whisky à l’empreinte écologique la plus faible possible », déclare Mme Thomas.




73
Bringing in state-of-the-art distilling equipment to the rural peninsula was a major investment – and risk – but one that Thomas felt confident in. The brand’s flagship Organic Single Malt Scotch Whisky comes to life through the slow and gentle fermentation of organic Scottish barley, distilled and then blended from select batches of Nc’nean’s 3,000-plus cask collection, made up of two types of barrels – bourbon and STR (shaved, toasted, re-charred). Installer un équipement de pointe dans la péninsule rurale représentait un investissement majeur – et un risque considérable –, mais Mme Thomas avait confiance. L’Organic Single Malt Scotch Whisky, produit phare, naît de la lente et douce fermentation d’orge écossaise bio, et est distillé puis assemblé à partir de lots sélectionnés dans la collection de plus de 3000 tonneaux de Nc’nean, composée de deux types de fûts : de bourbon et STR (grattage, bousinage, recarbonisation).




74
Water is a major factor in the environmental sustainability of whisky production since the distilling process, specifically the cooling step, is very water intensive. Traditionally, water would be gathered from a high-energy cooling tower, but instead, Thomas decided to dig a large pond on site, which acts as a natural water-cooling system. Another creative no-waste solution: Remains of the organic barley grains are fed to cows at the farm next door and liquid leftover from the distilling process is used as soil fertilizer. L’eau est un facteur central dans la production durable de whisky, puisque le procédé de distillation, surtout l’étape de refroidissement, en exige énormément. Traditionnellement, on la recueillerait dans une tour de refroidissement gourmande en énergie, mais Mme Thomas a plutôt décidé de creuser un grand étang sur le site, créant un système naturel. Autre solution novatrice zéro déchet : les vaches de la ferme voisine sont nourries des drêches d’orge bio, et la vinasse résultant du processus de distillation est utilisée comme engrais.

75
A few hours from Nc’nean Distillery, accessible by car and ferry from nearby Lochaline Harbour, the town of Oban (and its iconic fish shack) is a jumping-off point for the Inner Hebrides. The Port of Oban fish shack serves just-caught fish and mussels to a long line of hungry visitors every time a ferry docks. The picturesque Isle of Iona, located across the Isle of Mull from Oban, is known for its beautiful beaches and iconic abbey. À quelques heures de la distilleries Nc’nean par le traversier partant du port de Lochaline, Oban (et sa cantine de produits de la mer emblématique) est un point de départ pour les Hébrides intérieures. La cantine d’Oban sert poisson et moules fraîchement pêchés à une longue file de visiteurs affamés à chaque arrivée du traversier. La pittoresque île d’Iona, située de l’autre côté de l’île de Mull, à partir d’Oban, est connue pour ses belles plages et sa célèbre abbaye.




76

Survival of the Sweetest La survie du plus sucré
In Quebec’s Hautes-Laurentides region, the Desrochers name is synonymous with honey and mellowing the impacts of climate change. Dans les Hautes-Laurentides, au Québec, le nom Desrochers est synonyme de miel et d’adoucissement des effets des changements climatiques.
BY PAR CAITLIN STALL-PAQUET PHOTOS BY DE DOMINIQUE LAFOND


I hear beekeeper Anicet Desrochers at work before I see him. Reggae beats and puffs of steam surround him inside the small rickety barn where he sits hunched over a wood-framed honeycomb with a tiny paintbrush-like instrument in his hand. It’s not until his business and life partner Anne-Virginie Schmidt turns down the music that he looks up from his careful work of extracting eggs from waxy hexagonal cells. As he starts to explain his craft, he points to the hills outside his window, where 50 of his 1,200 hives house the best bees. From these, the shaggy-haired apiarist harvests larvae that become the 13,000 to 15,000 queens he sells to beekeepers across Canada each summer.

I’m at Miels d’Anicet apiary in Ferme-Neuve, Quebec, roughly 280 kilometers north of Montreal, to learn about Desrochers’ ambitious decades-long project of breeding bees that are more resilient to climate change’s unpredictable weather and to the pathogens that decimate hives. Desrochers’ fascination with bees stretches back 20 years, and many of his skills are based on observation, experimentation and techniques gleaned over time. But he has the pedigree, too: After finishing his beekeeping studies at Alberta’s
J ’ entends l’apiculteur Anicet Desrochers travailler avant de le voir. Rythmes reggae et nuages de va peur l’enveloppent dans la petite grange délabrée où il est penché sur un cadre de ruche en bois, tenant un petit outil tel un pinceau fin. C’est seulement quand sa conjointe et associée Anne-Virginie Schmidt baisse le son qu’il lève les yeux de sa tâche minutieuse : prélever des œufs sur des alvéoles hexagonales cireuses. Il se met à expliquer son art, indiquant les collines, visibles par la fenêtre, où 50 de ses 1200 ruches abritent les meilleures abeilles. L’homme échevelé y récolte les larves qui donneront les 13 000 à 15 000 reines qu’il vend chaque été aux apiculteurs du Canada.
Je suis aux Miels d’Anicet à Ferme-Neuve, au Québec, à environ 280 km au nord de Montréal, pour en savoir plus sur son ambitieux projet, vieux de dizaines d’années, d’élever des abeilles résistant mieux aux changements climatiques et aux agents pathogènes qui déciment les ruches. Sa fascination pour les abeilles remonte à 20 ans, et nombre de ses compétences reposent sur l’observation, l’expérimentation et des techniques développées avec le temps. Mais il a aussi la formation : il a fait des études d’apiculture au Collège de Fairview en Alberta,
With a scapular tool, Anicet Desrochers grafts larvae one by one from honeycomb frames. À l’aide d’un outil spécialisé, Anicet Desrochers prélève les larves une à une dans les alvéoles.
The geographic isolation of the farm’s mating stations preserves the genetic stock of hardy reproductive queens. L’isolement géographique des ruchettes de la ferme préserve le stock génétique de reines reproductrices robustes.
OPENING SPREAD EN OUVERTURE
Beekeeping is a family affair for partners Anne-Virginie Schmidt and Anicet Desrochers (and their daughter Melia). L’apiculture est une affaire de famille pour Anne-Virginie Schmidt et Anicet Desrochers (et leur fille Melia).

When You Go Sur place
STAY OÙ LOGER
Camp or glamp at the lakeside Montagne du Diable Regional Park where rustic tiny houses with backyard barbecues share the woods with a walking trail leading to a waterfall and a cabin named after the local honey makers. Rent a paddleboard or kayak to explore the waters and rest on offshore docks. Campez ou louez un prêt-à-camper au lac du parc régional Montagne du Diable, où des minimaisons rustiques avec barbecue avoisinent un sentier de randonnée menant à une chute et à un chalet du nom de la miellerie. Louez un surf à pagaie ou un kayak pour explorer les plans d’eau et vous reposer sur les plateformes au large.
PARCMONTAGNEDU DIABLE.COM
80








www.hawksworthgroup.com 604.605.3325 excellence in hospitality, driven by creativity and quality
Fairview College, he completed an internship at an apiary in California under veteran beekeeper Rick Schubert before launching into the buzzy biz himself.

Not long after starting out, an article in Bee Journal gave Desrochers the idea to raise darker, docile alpine bees that could better absorb heat, like a Slovenian variety he brought to Quebec. He crossbred these with the East African subspecies Apis mellifera monticola to create a hyper-resistant and adaptable breed he calls the “Mustang of bees.”
Here amid the lush Laurentian hills, it’s hard to imagine the far-from-idyllic fact that, like for many in the business, 2021 delivered the worst honey yield in the beekeeper’s history – 50 percent less than in previous years. As we talk about the impacts of drought, spring frosts that kill budding blooms and long summers that allow parasites like the Varroa destructor mite to proliferate, I start to grasp the invisible responsibility the climate crisis has layered onto the term beekeeper. “We’re too mythical,” says Desrochers. “We’re never seen, since we’re in the woods, quietly working, listening to reggae. Nobody knows what we do.” This is one of the reasons, according to Desrochers, the government doesn’t act in the face of drastic bee population declines until it’s too late.
I leave Desrochers to his weekly larvae extraction and follow Schmidt to a boutique where the warm aroma of beeswax, honey and herbs saturates the bright space like the olfactory equivalent of afternoon light. To complement the farm’s agro-tourism business, the family runs an on-site boutique housing a product line
puis un stage dans une miellerie californienne auprès du vétéran Rick Schubert avant de se lancer à son compte. American Bee
lui a donné l’idée d’élever de dociles abeilles alpines dont la couleur foncée pourrait mieux absorber la chaleur, par exemple d’une lignée slovène qu’il a introduite au Québec et croisée avec la sous-espèce Apis mellifera monticola , d’Afrique de l’Est, pour créer une lignée adaptable et hyper résistante, qu’il qualifie de « la Mustang des abeilles ».
Dans ces vertes Laurentides, difficile d’imaginer que, comme pour nombre de ses collègues, 2021 a donné la pire récolte de sa carrière, en baisse de 50 % par rapport aux années précédentes. Alors que nous discutons des effets de la sécheresse, des gelées printanières qui tuent les fleurs naissantes et des longs étés qui favorisent la prolifération de parasites tels que le varroa, je commence à saisir la responsabilité invisible dont la crise climatique charge le mot apiculteur. « Nous sommes trop mythiques, dit M. Desrochers. On nous voit peu, car nous sommes dans les bois, à travailler patiemment en écoutant du reggae. Nul ne sait ce que nous faisons. » C’est une des raisons pour lesquelles, selon lui, le gouvernement n’agit face au déclin dramatique des populations d’abeilles que quand il est trop tard.
Laissant M. Desrochers à son prélèvement hebdomadaire, je suis Mme Schmidt jusqu’à une boutique où un doux arôme de cire d’abeille, de miel et d’herbes emplit l’espace. En complément de la ferme agrotouristique, la famille gère ce commerce où une ligne de produits porte le nom de sa fille, Melia, plus un resto saisonnier
Beekeeper Billy Morin searches for the queen, which can be identified by its larger size and longer abdomen.
L’apiculteur Billy Morin cherche la reine, plus grande et à l’abdomen plus long que les autres abeilles.
EAT OÙ MANGER
At Cantine Pollens & Nectars, chef Jonathan Boerboom brings flavours from his Vietnamese heritage to Quebec ingredients. Between fluffy focaccia served with honey butter, beef tartare topped with rootvegetable chips, and an herbaceous banh xeo minh packed with lobster and pork, every bite during this meal is sweet in one way or another.
À la Cantine Pollens & Nectars, le chef Jonathan Boerboom combine les saveurs de son héritage vietnamien et les ingrédients québécois.
Entre la focaccia moelleuse servie avec beurre au miel, le tartare de bœuf garni de croustilles de légumesracines et un banh xeo minh herbacé débordant de homard et de porc, chaque bouchée est sucrée d’une manière ou d’une autre.
MIELSDANICET.COM
83


Honey is served straight from the comb over table toppers dotted with facts about apiculture. Le miel, servi en rayons, se savoure sur des napperons émaillés de faits sur l’apiculture.

PREVIOUS SPREAD PAGES PRÉCÉDENTES
Carry-on luggage: After foraging fields of goldenrod and clover, bees fly home with their saddlebags full of pollen. Chargées à bloc: ayant butiné des champs de solidage et de trèfle, les abeilles rentrent à la ruche, corbeilles à pollen pleines.
named after their daughter, Melia, and in 2017, opened a seasonal hive-to-table restaurant, Cantine Pollens & Nectars. Diversification is important for the couple’s livelihood, since their beauty, wellness, and food and drink products carry them through low honey years.
After showing me the workshop, Schmidt, who has taken honey-tasting courses at the Culinary Institute of Bologna, lines up seven jars on a table in the staff kitchen. She arranges them in order of intensity, from a light, filtered spring honey to an opaque, nutty and grassy buckwheat version that’s almost savoury as it coats my tongue in autumn flavours. About 12 years back, Desrochers convinced nearby farmers to plant buckwheat, which is more nutritious for bees than crops like transgenic canola or soy. Through this tweak in the landscape, he’s grown a more symbiotic relationship with local organic farmers, who have reaped benefits from sowing the hardy, fast-growing kernels, too.
We taste honeys in sequence, discussing their complexity, texture and tasting notes like we might talk about wine. Schmidt teaches me about the guesswork of apiculture, and how they can never be absolutely sure what bees will bring back to the hive. Last spring, Miels d’Anicet made a surprise small batch of honey after Desrochers detected maple and willow during sampling and confirmed his hunch via pollen analysis. During my July visit, they haven’t had a drop of honey yet – another alarming change – though the keepers are optimistic given the season’s heavy rainfall. They can sense the liquid gold rush coming.
Later in the afternoon, I don a bee suit, and follow Desrochers and his wingman Billy Morin into fields of waist-high grasses grown wild with daisies and bluestar blossoms to see the densely packed hives and their inhabitants up close. We walk up a hill dotted with
de proximité ouvert en 2017, la Cantine Pollens & Nectars. Se diversifier est important pour la famille, dont les produits gourmands et de soins corporels lui permettent de traverser les années de faible production de miel.
Après m’avoir montré l’atelier, M Schmidt, qui a suivi des cours de dégustation de miel à l’Institut culinaire de Bologne, aligne sept pots sur une table de la cuisine du personnel, en ordre d’intensité, d’un miel de printemps clair à un miel de sarrasin foncé aux notes de noix et d’herbes, aux saveurs d’automne presque salées. Il y a une douzaine d’années, M. Desrochers a convaincu des fermiers du coin de planter du sarrasin, plus nutritif pour les abeilles que le canola ou le soya transgéniques. Il a ainsi noué une relation plus symbiotique avec les bioagriculteurs locaux, à qui semer cette céréale rustique à croissance rapide a aussi profité.
Nous goûtons les miels dans l’ordre, discutant com plexité, texture et notes de dégustation comme si c’était des vins. Mme Schmidt m’explique les aléas de l’apiculture, du fait qu’on ne peut jamais être certain de ce que les abeilles vont rapporter à la ruche. Au printemps dernier, Miels d’Anicet a produit un petit lot surprise quand M. Desrochers a détecté des traces d’érable et de saule à l’échantillonnage et confirmé son intuition après analyse pollinique. À mon passage, en juillet, les apiculteurs n’ont pas encore une goutte de miel, autre changement alarmant, mais sont optimistes, vu les fortes pluies de l’été. Ils anticipent une éruption d’or liquide.
Plus tard en après-midi, en combinaison apicole, je suis M. Desrochers et son bras droit Billy Morin dans des champs de marguerites et d’amsonies où les graminées nous montent à la taille, pour voir de près les ruches bondées et leurs habitantes. Nous montons une colline parsemée de stations de fécondation, des boîtes dont les couleurs vives aident les abeilles à reconnaître leur
SHOP QUOI ACHETER
Honey varieties and the healing benefits of beeswax take the spotlight at the apiary’s hilltop store. Soaps, lip balms and ointments line shelves alongside honey-spiked mustards, Desrochers family meads and, of course, jars of the unpasteurized nectar.
Les variétés de miel et les vertus curatives de la cire d’abeille sont à l’honneur dans la boutique de la miellerie, en haut d’une colline. Savons, baumes à lèvres et onguents côtoient moutardes au miel, hydromels de la famille Desrochers et, bien sûr, pots de miel non pasteurisé.
@MIELSDANICET
86

® Aeroplan is a registered trademark of Aeroplan Inc., used under licence. ®The Air Canada maple leaf logo is a registered trademark of Air Canada, used under licence. MD Aéroplan est une marque déposée d’Aeroplan Inc., utilisée sous licence. MD Le logo de la feuille d’érable d’Air Canada est une marque déposée d’Air Canada, utilisée sous licence. 1) Earn up to 10pts/$1 with 200+ retailer. Download the Aeroplan shopping button. SHOP 2 WAYS VIA THE AEROPLAN ESTORE: 2) Redeem points for 2000+ products and 150+ gift cards. 1) Obtenez jusqu’à 10 points par dollar dépensé auprès de plus de 200 détaillants. Téléchargez le bouton de magasinage d’Aéroplan. MAGASINEZ DE DEUX FAÇONS VIA LA EBOUTIQUE AÉROPLAN : 2) Échangez vos points, et choisissez parmi plus de 2 000 produits et plus de 150 cartes-cadeaux. SHOP NOW MAGASINER EARN REDEEM & BE MERRY ACCUMULEZ ÉCHANGEZ ET CÉLÉBREZ

brightly coloured bees recognize to as an isolated mating station. Morin removes a frame swarming with bees, pointing out the alpine breed’s darker colour. He and Desrochers immediately spot the queen, who is larger than the hundreds of worker bees scurrying on the comb, with a longer, more slender abdomen that has evolved exclusively to produce eggs.

grouillant d’insectes, la lignée alpine. M. Desrochers et lui repèrent immédiatement la reine, plus grande que les centaines d’ouvrières qui s’affairent dans les alvéoles, et dont l’abdomen long et fin s’est développé dans le seul but de pondre des œufs.
On summer nights, Cantine Pollens & Nectars lights up like a hive, buzzing with diners and apron-clad worker bees.
Les soirées d’été, la Cantine Pollens & Nectars bourdonne de clients et d’employés en tablier.
Hives are colour-coded so bees don’t bumble into the wrong colony. Flower-like hues are favoured over blacks and browns.
Les abeilles retrouvent leur ruche par la couleur. On préfère les teintes du monde des fleurs au noir ou au brun.
As the sun turns golden, we head back to the cantine, where visitors are being rewarded for the bees’ labour. We sit by the huge windows that overlook Montagne du Diable and I sip a glass of their happy-hour-ready version of low-alcohol piquette, Beezquette, infused with spruce from the trees that line the mountain’s slopes. Later, bottles of Quebec, French and Italian natural wine emerge from the cellar. Much like with honey, Desrochers’ wine palette has a predilection for audacity and the right amount of funk. After we cheers, a diner stops by to thank the owners for opening in their town. The duo beams, saying this is what motivates them when the going gets tough.
A gentle wind bends through the wild fields left to grow free under the light direction of Desrochers’ guiding hand. As he surveys the expanse, it’s clear he views himself as part of the landscape rather than its owner. “Our playground is beautiful,” he says. “It’s there just asking for us to express ourselves and bring out its potential.” I realize he applies this idea of selfexpression to the bees, too, as if he and the pollinators he adores are equals. We’ve altered our landscapes since agricultural societies developed some 12,000 years ago, and we continue to impact our environments, for better or worse. Desrochers knows that adaptation is part of the keeper’s creed. In his own quiet way, he’s sowing the seeds of a sweeter future.
Au soleil couchant, nous rentrons à la cantine, où les visiteurs sont récompensés par le travail des abeilles. Nous nous attablons près des fenêtres qui donnent sur la montagne du Diable et je sirote un verre de Beezquette, la piquette maison à faible teneur en alcool idéale pour le 5 à 7, aromatisée aux bourgeons des épinettes qui bordent ses pentes. Plus tard, des bouteilles de vins nature québécois, français et italien émergent de la cave. Comme pour le miel, la palette de vins de M. Desrochers tend vers l’audace et une bonne dose de robustesse. Nous trinquons, puis une cliente s’arrête pour remercier les propriétaires d’être venus s’établir dans sa ville. Le couple se réjouit, ajoutant que c’est ce genre de commentaire qui le motive quand les temps sont durs.
YUL Economy seats to Montreal from 4,200 points Places en classe économique à partir de 4200 pointsPOINTS DISPLAYED ARE ESTIMATED RANGES FOR ONE-WAY TRAVEL AND ARE FOR INFORMATIONAL PURPOSES ONLY SEUIL MINIMAL DE POINTS AÉROPLAN FOURNI À TITRE INDICATIF SEULEMENT, ESTIMÉ SUR LA BASE D’UN ALLER SIMPLE
Une douce brise courbe les prés sauvages qui s’épa nouissent librement sous la légère supervision de M. Desrochers. Quand il observe l’étendue de la ferme, il est clair qu’il se voit comme faisant partie du paysage plutôt qu’en propriétaire. « Notre terrain de jeux est splendide, affirme-t-il. Il nous demande juste de nous exprimer et de valoriser son potentiel. » Je réalise qu’il applique cette idée d’expression personnelle aux abeilles aussi, comme si les insectes pollinisateurs qu’il adore et lui étaient égaux. Nous avons modifié le paysage depuis la venue des sociétés agraires, il y a quelque 12 000 ans, et continuons à agir sur l’environnement, pour le meilleur ou pour le pire. Anicet Desrochers sait que s’adapter fait partie du credo de l’apiculteur. À sa manière tranquille, il sème les graines d’un avenir mielleux.
89



Croquez. Craquez. Voyagez. Crunch. Go nuts. Faites le plein d’énergie. Disponible sur ce vol. Fill up on energy. Available on this flight. Entreprise 100% canadienne. 100% Canadian Company.
Altitude
BANGKOK BOUND LA LIAISON BANGKOK
Wheels up: Starting December 1, 2022, Air Canada’s Boeing 787-9 Dreamliner aircraft will head west with the launch of non-stop seasonal service to Bangkok from Vancouver International Airport. Crossing 11,819 kilometres, the nearly 16-hour flight will be the first direct route from North America to Bangkok in more than a decade. En altitude : À compter du 1er décembre 2022, les Boeing 787-9 Dreamliner d’Air Canada mettront le cap sur l’Ouest, avec le lancement d’un service saisonnier sans escale à destination de Bangkok, au départ de l’aéroport international de Vancouver. D’une durée de près de 16 heures, ce vol de 11 819 km sera la première liaison directe entre l’Amérique du Nord et Bangkok depuis plus d’une décennie.
 PHOTO: LAIRD KAY
PHOTO: LAIRD KAY
PLAN YOUR NEXT ADVENTURE WITH AIR CANADA PLANIFIEZ VOTRE PROCHAINE AVENTURE AVEC AIR CANADA
Global route network Réseau international
Air Canada is the nation’s largest airline and a major provider of scheduled customer services in the Canadian market, the U.S. transborder market and the international market to and from Canada.
Air Canada est le plus important transporteur du pays et le principal fournisseur de services passagers réguliers dans les marchés canadien, transfrontalier et international au départ et à destination du Canada.
Bangkok Auckland
Air Canada and Air Canada Rouge routes Vols d’Air Canada et d’Air Canada Rouge
92 RÉSEAUROUTES
Bangkok Auckland
Calgary











Toronto
Vancouver
93ROUTESRÉSEAU
Doha Doha
Honolulu Calgary Maui Toronto Honolulu
Maui
Kailua Kona Vancouver Bangkok ROUTES LAUNCHING DECEMBER 2022 LIAISONS LANCÉES EN DÉCEMBRE 2022
North America route network
Notre réseau en Amérique du Nord
Air Canada, Air Canada Rouge and Air Canada Express routes
Vols d’Air Canada, d’Air Canada Rouge et d’Air Canada Express
94
Orange County Orange OrangeCounty County
RÉSEAUROUTES
ROUTES LAUNCHING DECEMBER 2022
LANCÉES EN DÉCEMBRE 2022
Halifax Tampa Vancouver
95ROUTESRÉSEAU
Miami
LIAISONS
Caribbean route network Notre réseau dans les Antilles
Halifax Cancún
Halifax Punta
Montréal Antigua Montréal Bridgetown Montréal Ixtapa
Montréal San Juan
Ottawa Varadero
Quebec City / Québec Cayo
Quebec City / Québec Varadero Toronto Belize
MONTR
NORTH ATLANTIC OCEAN
OC É AN ATLANTIQUE NORDOCÉAN
TURKS AND CAICOS (U.K.) TURKS ET CAICOS (R.-U.)
TURKS (U.K.) ET
St. Maarten Saint-Martin
Saint-Christophe
PUERTO
PUERTO RICO (U.S.) PORTO RICO (É.-U.)
VENEZUELA VENEZUELA
GUYANA GUYANE GUYANA
GUADELOUPE (FRANCE)
MARTINIQUE (FRANCE)
BARBADOS BARBADE
FRENCH
FRENCH GUIANA
96
CARIBBEAN SEA MER DES CARA Ï BES CARAÏBES GULF OF MEXICO GOLFE DU MEXIQUE
BRAZIL BRÉSIL BRAZIL BRÉSIL
GUYANE FRANÇAISE
GUIANA FRANÇAISE SURINAME
COLOMBIA COLOMBIE COLOMBIA COLOMBIE PANAMA PANAMÁ COSTA RICA RICA NICARAGUA ELNICARAGUA SALVADOR SALVADOR EL HONDURAS HONDURAS GUATEMALA BELIZE
CUBA BAHAMAS
JAMAICA JAMAÏQUE HAITI HAÏTI DOMINICAN REPUBLIC RÉPUBLIQUE DOMINICAINE MEXICO MEXIQUE MEXIQUE UNITED STATES ÉTATS-UNIS UNITED STATES ÉTATS-UNIS CANADA CANADA Varadero
St. Kitts
St. Lucia Sainte-Lucie St. Vincent Saint-Vincent Santa Clara San Juan San José San Salvador Samaná Samaná Punta CanaPunta Cana Puerto Vallarta Panama City Huatulco Ixtapa Puerto Plata Providenciales Pointe-à-Pitre Nassau Montego MontegoBay Bay Liberia Kingston Holguín Havana La LaHavane Havane Grenada Grenade Grand Cayman Grand Caïman George Town Fort-de-France Curaçao Cayo CocoCayo Coco Cancún Cozumel Bridgetown Bermuda Bermudes Belize City Aruba Antigua Mexico City Mexico TORONTO TORONTO
É AL MONTRÉAL Halifax Ottawa Ottawa Winnipeg Québec 1:100 KM 0 1 3 5 Air Canada and Air Canada Rouge routes Vols d’Air Canada et d’Air Canada Rouge RÉSEAUROUTES
Cana
Coco
City ROUTES LAUNCHING DECEMBER 2022 LIAISONS LANCÉES EN DÉCEMBRE 2022
SNONOW

This winter say no to snow and yes to WeatherTech. Just like a snowflake, the WeatherTech FloorLiner has unique curves and contours designed to perfectly fit the floor of your specific vehicle. But instead of leaving you with cold feet and soggy carpets, the WeatherTech FloorLiner will keep your boots clean and your carpets pristine. And with a lifetime guarantee, it’s tough enough to handle any winter adventure for as long as you own your vehicle.

WeatherTech.ca WeatherTech.com
Monteverde, Costa Rica
PHOTO BY READER DE LA LECTRICE STEPHANIE MADEIRA @SVIZRA__
On a winter escape to the Guanacaste Province in Costa Rica, writer and photographer Stephanie Madeira made her way through luscious green mountains to Café Monteverde, a coffee collective run by 18 local families. Adjacent to Monteverde Cloud Forest Biological Preserve, the farm and roastery offers tours and runs a program for learning about sustainable coffee production, from harvesting to cleaning, roasting and packaging. “It was an afternoon well-spent learning about how these beloved beans become a morning cup,” says Madeira. Lors d’une escapade hivernale dans la province de Guanacaste au Costa Rica, l’autrice et photographe Stephanie Madeira a sillonné les vertes montagnes jusqu’au Café Monteverde, une coop agricole gérée par 18 familles du cru. Adjacentes à la réserve biologique de forêt nuageuse de Monteverde, la ferme et la brûlerie offrent des visites guidées et une initiation à la production durable de café (récolte, nettoyage torréfaction, emballage). « Ça a été un après-midi très instructif où j’ai appris comment on transformait ces fèves bien-aimées en petits plaisirs du matin », dit-elle.
You too could have your photo featured in Air Canada enRoute. Share it with us @enroutemag + #enrouteplaceoftheday Votre photo aussi pourrait figurer dans Air Canada enRoute. Partagez-la @enroutemag + #lieudujourenroute

98 DE VOTRE POINT DE VUESHARE YOUR VIEWS
BLOCK THE BLUES
From digital screens to the sun, our exposure to blue light is greater than ever. Blokz ® offers the industry’s most advanced blue-light-blocking technology to help with reduced eye strain, improved sleep, and less headaches.

Add Blokz ® lenses to any Zenni frame for a custom pair of blue light glasses starting at CAD $26.95.
Get the Zenni App
zenni.com/blokz





























 Ériver Hijano Photographer Photographe
Ériver Hijano Photographer Photographe








 President and Chief Executive Officer Président et chef de la direction
President and Chief Executive Officer Président et chef de la direction

BY PAR NANCY MATSUMOTO PHOTOS BY DE VIRGINIE GOSSELIN
BY PAR NANCY MATSUMOTO PHOTOS BY DE VIRGINIE GOSSELIN

































































































































 PHOTO: LAIRD KAY
PHOTO: LAIRD KAY





